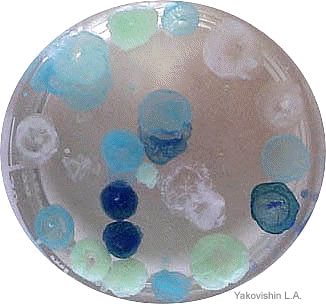

|

Студентам
СевГУ

Книжная
полка

Разное

Фото- и
видеогалерея

Занимательные
опыты

Полезные
ссылки

Справочник

Мир глазами химика

Шоколад: особенности
химического состава
|
|
|
|
|

Время учиться в Севастополе!
Севастопольский государственный университет
приглашает абитуриентов на
направление подготовки
18.03.01 Химическая технология |
|
 |
|
|
|
 |
|
21.05.2026 г. |
Красный день
календаря у красной рыбы. Сегодня
отмечается Международный день лосося |
Ловись, рыбка, красная!
Ловись с астаксантином!
Сделаем бутерброд с
такой рыбкой и выясним, почему же она красная.
Естественно, опять «виноватой»
будет вездесущая химия.
Красная окраска мяса
лососёвых рыб обусловлена наличием в нем
красителя астаксантина.
Это каротиноид красного цвета, относящийся в
ксантофиллам. Он же является причиной розового цвета
перьев у фламинго и окраски креветок, криля, омаров,
раков и некоторых водорослей и лишайников.
Это вещество
-
сильный антиоксидант.

Подробности
|
 |
|
19–21
мая 2026 г. |
У
СевГУ
I
место
на Международной научной
конференции «Химические проблемы современности
– 2026» |
В
Донецком государственном университете
прошла юбилейная
X
Международная научная конференция студентов, аспирантов
и молодых ученых «Химические проблемы современности».
Студенты Севастопольского
государственного университета,
будущие учителя химии и биологии, Анна Лысенко,
Виктория Пшеничная и Варвара Резник
представили на конференции разработку «Метапредметные
связи при изучении химии и истории в условиях средней
школы».
На кафедре «Химия и химические
технологии» СевГУ они занимаются исследованиями в
области методики преподавания химии (научный
руководитель профессор Яковишин Л.А.).
Экспертная комиссия конференции высоко
оценила доклад из СевГУ и присудила ему
I
место.
Поздравляем!

Подробности |
 |
|
13.05.2026 г. |
Всемирный
день одуванчика. У
«травы
бедняков»
сегодня праздник |
Всем известно, что если сорвать одуванчик, то из его
стебля начинает выделяться белая липкая жидкость
–
млечный сок (латекс). В нем содержится природный
каучук. Основным
компонентом природного каучука является
цис-полиизопрен (цис-поли-2-метил-1,3-бутадиен).
Он не растворяется в воде, но образует с ней стойкую
эмульсию, т.е. систему, в
которой частицы каучука распределены в жидкости (воде).
При
повреждении одуванчика млечный сок выполняет защитную
функцию, т.к. он является антисептиком и быстро
затвердевает, образуя тонкую каучуковую пленку.
Раньше некоторые виды одуванчика были промышленными
источниками для получения каучука.

|
 |
|
12.05.2026 г. |
Изучены перспективные ингибиторы отверждения гипса |
Ученые
Крымского федерального университета им. В.И.
Вернадского и
Севастопольского
государственного университета
исследовали
зависимость
ингибирующего действия моно-, ди- и тринатриевых
солей нитрилотриуксусной кислоты на процесс отверждения
гипса и сравнили ее с активностью других
соединений.
Оказалось, что
изученные
нитрилотриацетаты натрия как ретарданты более активны, чем динатриевая соль
этилендиаминтетрауксусной кислоты
(трилон
Б).

|
 |
|
29.04.2026 г. |
Легендарной
«Докторской»
колбасе исполнилось 90 лет! |
Первая «Докторская»
– послевоенное
«лекарство»
и средство от «царского деспотизма»
Первоначально колбаса предназначалась для
диетического питания людей, пострадавших от
голода во время Гражданской войны. Ее
обязательная рецептура регламентировалась
Наркомпищепромом СССР.
29 апреля 1936 г. нарком
А.И. Микоян
утвердил рецептуру «Докторской», разработанной
во Всесоюзном НИИ мясной промышленности.
Поэтому эту дату
обычно считают днем рождения «Докторской»
колбасы.

По рецептуре 1936 г.
«Докторская»
колбаса состояла только из
7
ингредиентов: свинины жирной и нежирной, говядины, соли,
сахара, селитры и кардамона.
Подробности
|
 |
06.04.2026 г.
В СевГУ разработаны
практико-ориентированные задания
для подготовки будущих учителей химии
Ученые
Севастопольского
государственного университета разработали
практико-ориентированные задания по неорганической
химии, которые повысят компетентность будущих учителей.
Предложенный
кейс предназначен для дисциплины
«Неорганический синтез».
Результаты
опубликованы в журнале ВАК "Казанская
наука".

|
 |
16.03.2026 г.
Сегодня День туши для
ресниц.
Токсичные соединения
свинца и сурьмы, сажа и даже помёт. Чем только не красили ресницы наши
предки!
В Древнем мире для подкрашивания
ресниц и подвода глаз использовали угольный порошок,
золу, пепел,
сажу, а также измельченные минералы: серые
галенит (сульфид
свинца(II)
PbS)
и антимонит (сульфид сурьмы(III)
Sb2O3), а также
черный тенорит (оксид меди(II)
CuO). Да,
красота требовала жертв. И они, к сожалению, были. Сами пигменты
смешивались с жиром, мёдом, а иногда даже с помётом. И не важно, что
средство было с душком, главное, что красиво и эффектно!

Подробности
|
 |
16.03.2026 г.
День
цветных карандашей
Этот инструмент для
рисования, всем знакомый еще с детства, имеет довольно давнюю историю. Еще до нашей эры
применяли подкрашенный воск.
Пигментами служили измельченные
минералы разных цветов.

Подробности
|
 |
8 марта
2026
г.
Юбилей у
Корж Елены
Николаевны
– к.х.н.,
доцента кафедры «Химия
и химические технологии» Севастопольского
государственного университета

Елена Николаевна
родилась 8 марта г. в г. Ереване. В 1952 г.
переехала в Севастополь, где окончила школу № 3. В 1964
г. поступила в Севастопольский приборостроительный
институт на специальность «Физико-химические
исследования металлургических процессов (защита от
коррозии)». Это был второй набор
студентов на новую тогда для Севастополя специальность.
В 1969 г. окончила
институт с отличием.
Подробности
|
 |
05.03.2026 г.
Обновлен раздел
"Химический юмор"
"Сахароза
– это заменитель сахара", "Солнце
излучает витамин В, и он летит через
космос к нам", "Элемент
голландий назван в честь Курчатова", "Пурген
–
это снотворное".
Обновлен раздел
"Химический
юмор".



|
 |
02.03.2026 г.
Международный
день спички
Самым
древним прообразом современных спичек были серные
спички. Об их существовании упоминалось еще в 1 веке.
Для получения таких спичек деревянные палочки и щепки
обмакивалась в расплавленную серу.
Они не были источником огня, т.к. сами не
зажигались, а служили для его переноса или облегчали его
разведение.
При "работе"
современных спичек
происходят
несколько окислительно-восстановительных химических реакций,
в результате которых они зажигаются и горят.

|
 |
16.02.2026
–
22.02.2026 г.
Проходит
Масленица
Какая же Масленица без блинов со сливочным маслом. С
точки зрения химии, сливочное масло –
это эмульсия, т.е.
дисперсная система, в
которой частицы одной жидкости распределены в другой
жидкости. В случае масла вода
(дисперсная фаза) находится в
жире (дисперсионной
среде).
Эмульсиями еще являются молоко, майонез и сливки.
Занимательные эксперименты со сливочным маслом

|
 |
09.02.2026 г.
Юные ученые из Севастополя и Симферополя поделились
результатами своих исследований на конференции в СевГУ
В
Институте ядерной энергии и промышленности
Севастопольского
государственного университета
состоялась
VII региональная
научно-практическая конференция студентов и школьников
«Первые шаги в науку».
Мероприятие прошло при
поддержке
концерна
«Росэнергоатом».

Тематика 14
докладов юных исследователей из Севастополя (гимназия №5,
СОШ №9, №31, №54, Экотех+, лицей-предуниверсарий и
Морской колледж СевГУ) и Симферополя (академическая
гимназия) была достаточно актуальной и разнообразной.
Это коррозионные процессы, вопросы энергетики,
утилизации и переработки различных отходов, очистка
сточных вод, IT-технологии,
биохимические процессы, разработка установки по
возникновению электрической дуги и даже
крымское краеведение.
Подробности
|
 |
08.02.2026 г.
День российской науки. Поздравляем научных
работников, преподавателей, аспирантов и студентов с
научным праздником! Новых достижений и открытий!

|
 |
07.02.2026 г.
Эффективные детектирующие реагенты для
хроматографии
Ученые
Крымского федерального университета им. В.И.
Вернадского и
Севастопольского
государственного университета
оценили
эффективность
различных детектирующих реагентов для
тонкослойной хроматографии с точки зрения предела
обнаружения
и различий в окраске хроматографических зон разных рядов
тритерпеноидов. Наилучший
результат показали реагенты на основе
фосфорновольфрамовой кислоты
H7[P(W2O7)6]
с
добавками ароматических альдегидов
(пара-оксибензальдегида и ванилина).

|
 |
02.02.2026 г.
Проведен скрининг природных и синтетических
полимеров, влияющих на отверждение гипса
Ученые
Крымского федерального университета им. В.И.
Вернадского и
Севастопольского
государственного университета
рассмотрели
влияние водорастворимых природных,
полусинтетических и синтетических полимеров на процесс
отверждения строительного гипса.
При этом нейтральные
полимеры либо не обладают
ингибирующей активностью, либо проявляют ее в
незначительной степени, однако
кислые полимеры имеют выраженное
ингибирующее
действие.

|
 |
22
декабря 2025 г.
День рождения электрической
елочной гирлянды
Новогодняя
гирлянда стала обычным символом Нового года. Но так было
не всегда. 22 декабря 1882 г. появилась первая
электрическая елочная гирлянда. Украшенная ей
рождественская ель стояла в Нью-Йорке в доме
изобретателя
Эдварда Джонсона
(1846–1917). Он
был соратником известного Томаса Эдисона (1847–1931),
который усовершенствовал лампу накаливания. Его лампа
имела угольную нить, полученную карбонизацией волокон
бамбука.
Гирлянда
Джонсона
состояла из 80 небольших белых, синих и красных
мигающих лампочек. В те времена это было настоящим
чудом. Причем ель еще и вращалась! До этого ели обычно
украшали только свечами.

Новогодняя
ель СевГУ
|
 |
22
декабря 2025 г.
Химия их связала.
Научные достижения
студентов СевГУ
Студенты, состоящие в
научном обществе, выполняют на кафедре
«Химия и химические технологии»
Севастопольского государственного
университета исследования по различным
направлениям – от фармацевтики до методики преподавания
химии в школе и вузе.

Подробности
|
 |
8–14
декабря 2025 г.
В России
проходит профилактическая неделя

В рамках этой недели на кафедре
«Химия и химические технологии» Севастопольского государственного
университета студенты групп Ф/б-23-1-о
и ПОхб/б-22-1-о провели научные
эксперименты.
Подробности
Подробности проведения экспериментов
|
 |
30
ноября
2025 г.
Всемирный день
домашних животных. Братья наши
меньшие способны влиять на нашу биохимию
–
менять концентрацию различных гормонов. Общение с ними
повышает уровень окситоцина
("гормона привязанности"),
серотонина ("гормона счастья") и
эндорфинов ("гормонов
радости"), но в тоже время уменьшает содержание гормона
стресса кортизола. Поэтому
контактируйте с домашними животными. Это положительно
отразится на вашем эмоциональном состоянии.

|
 |
19
ноября
2025 г.
День преподавателя высшей школы.
В Москве состоялась торжественная церемония награждения
победителей
Всероссийского конкурса
«Золотые
Имена Высшей Школы».
Конкурс
проводился Общероссийской общественной организацией
«Лига преподавателей высшей школы»
при поддержке Министерства науки и
высшего образования РФ.
В этом году на
конкурс было подано рекордное количество заявок
–
более 1250.
Севастопольский государственный университет тоже установил рекорд.
Семь его преподавателей стали победителями.
Среди них были и химики
–
кандидат химических наук, доцент
Лукина
Л.И. и доктор химических наук, профессор Яковишин
Л.А.

|
 |
03
ноября
2025 г.
Всемирный день медуз.
Чтобы увидеть этих необычных животных (а медуз относят
именно к ним), состоящих в основном из воды, можно
поехать к морю или сходить в аквариум. Но можно призвать
на помощь и химию. Для получения подобия
разноцветных медуз понадобится
жидкое стекло или
силикатный
клей.
Подробности
здесь.
|
 |
13-17 октября 2025
г. В
Институте физиологии растений им.
К.А. Тимирязева РАН (г.
Москва) проходит
XII
Всероссийский симпозиум с
международным участием
«Фенольные соединения:
фундаментальные и прикладные аспекты».

Кафедры
"Химия и
химические технологии"
и "Физика"
Севастопольского
государственного университета
представили на этом научном мероприятии в рамках
направления "Нано-,
био-, аква- и
фармтехнологии на
основе фенольных соединений"
результаты исследования новых комплексов
рутина и
кверцетина.
|
 |
28
сентября
2025 г. Этот день
традиционно считают датой
открытия пенициллина
–
первого антибиотика.
Произошло данное историческое событие в 1928 г.
благодаря бактериологу А.
Флемингу (1881–1955).
Однако им было
получено не индивидуальное вещество, а смесь c сопутствующими примесями.
Чистый пенициллин
G
(бензилпенициллин)
был
выделен только в
1940 г.

В
Севастопольском
государственном университете на кафедре "Химия и
химические технологии"
разработаны
занимательные химические
опыты с пенициллиновыми антибиотиками. Результаты
опубликованы в журнале "Химия в
школе".
|
 |
27 сентября (10
октября по новому
стилю)
2025 г.
120 лет
назад
были торжественно открыты памятники, посвященные Первой
обороне города Севастополя (1854–1855
гг.). Среди них был и
Памятник затопленным кораблям.
Он
является самым известным памятником Севастополя и его главным
символом.

Подробнее о
Памятнике затопленным кораблям
|
 |
22-27.09.2025
г.
В Севастопольском государственном университете проходит
XX юбилейная
Международная научная конференция "Актуальные вопросы
биологической физики и химии. БФФХ-2025".
Тематические направления этой
конференции включают
различные
вопросы общей и молекулярной
биофизики, биоинформатики и биофизической экологии,
медицинской биофизики и биофизической химии.
Второй этап этого научного форума состоится в
Московском государственном
университете им. М.В. Ломоносова с 7 по 12
октября.

|
 |
20
сентября
2025 г. День
сока в России. Этот праздник
отмечается с 2013 г. в
третью субботу сентября. В этот праздничный день мы
предлагаем не только выпить сок, но и провести с ним
занимательные эксперименты. Тем более, что врачи
рекомендуют ежедневно употреблять не менее 400 г овощей
и фруктов (5 порций по 80 г),
одну порцию можно заменить соком.

Занимательные опыты с
соком
|
 |
15
сентября
2025 г. В этот день (3 сентября по
старому стилю) в 1828 г. родился великий русский химик Александр Михайлович Бутлеров
(1828–1886),
создатель теории строения
органических веществ.

Памятник
А.М.
Бутлерову в Казани
Подробнее о теории строения органических веществ
|
 |
13
сентября
2025 г. Опять все
будет в
шоколаде! В этот день
отмечается еще один Всемирный день шоколада.
Да, у шоколада есть еще несколько праздничных дней –
7 и 11 июля.

Подробнее о
шоколаде
Занимательные опыты с
шоколадом |
 |
01
сентября
2025 г.
«Золотые
химики»
СевГУ.
Подведены итоги
Всероссийского конкурса
«Золотые
имена высшей школы»
2025 года.
Он
проводится Общероссийской общественной организацией
«Лига преподавателей высшей школы»
при поддержке Министерства науки и
высшего образования РФ.
Семь преподавателей Севастопольского государственного
университета стали победителями этого конкурса.
Среди них кандидат химических наук, доцент Лукина
Л.И. и доктор химических наук, профессор Яковишин
Л.А.

|
 |
27
августа
2025 г.
Получены композит
и микрокапсулы на основе хитозана и
изучены их адсорбционные свойства.

В
Севастопольском
государственном университете на кафедре "Химия и
химические технологии"
исследован
композит полисахарида
хитозана с додецилсульфатом
натрия и его комплекс с катионами свинца(II).
Определены оптимальные условия
формирования
микрокапсул хитозана с оболочкой хитозан–додецилсульфат.
Полученные микрокапсулы
обладают
высокой
степенью
извлечения ионов свинца из водных растворов
и
являются более эффективным сорбентом
этих ионов, чем индивидуальный комплекс хитозан–додецилсульфат.
Разработанные сорбенты могут быть перспективными для
очистки сточных вод от катионов тяжелых металлов.
Исследования выполнены доцентом Ткаченко Э.В., профессором
Яковишиным Л.А.,
доцентом Федоровой С.А. и студентом Русяевым
С.В.
Хитозан
–
природный полимер, получаемый из
хитина ракообразных и
насекомых. Он проявляет иммуномодулирующую,
противоопухолевую, антиоксидантную, бактериостатическую
и фунгистатическую активность, имеет высокую
биосовместимость к тканям человека и обладает
отличными сорбционными свойствами.
|
 |
23
августа
2025 г.
Исследование известного
всем антисептика
"зеленка" продолжается.
"Зеленкой" в быту
называют культовое лекарство
бриллиантовый зеленый,
относящееся к группе трифенилметановых красителей.
Он используется в медицинской практике для обработки
свежих посттравматических и послеоперационных ран и
ссадин. Также его применяют при пиодермии и блефарите.

Бриллиантовый зеленый
–
известная всем у нас "зеленка"
В
Севастопольском
государственном университете на кафедре "Химия и
химические технологии"
разработаны методики
химико-фармацевтического анализа
бриллиантового
зеленого на фильтровальной
бумаге капельным способом. Показаны преимущества их
использования в таком варианте
проведения
идентификации лекарства.
Подробнее об экспериментах с "зеленкой"
|
 |
16 июля (29 июля
по новому стилю)
2025 г. 120 лет назад
были завершены работы по сооружению
Памятника затопленным кораблям.
Он
является самым известным памятником Севастополя и его главным
символом. Изображен на гербе города. Монумент установлен к 50-летию Первой обороны города
(1854–1855 гг.).

Подробнее о
Памятнике затопленным кораблям
с
точки зрения химии
|
 |
11 июля все
будет в
шоколаде! Именно в этот день
отмечается Всемирный день шоколада.
В 2025 году
шоколадному празднику исполняется уже 30
лет.


Как известно, шоколад – это кондитерское
изделие, которое готовят на основе
какао-продуктов
(масла какао, какао тертого, какао-порошка,
какао-крупки).
Подробнее о
шоколаде |
 |
02 июля 2025 г.
Международный день
собак.
Как
известно, М.В. Ломоносов говорил:
«Широко
простирает химия руки свои в дела человеческие».
Достижения современной химии
активно используются в ветеринарии
и зоотехнии,
что позволяет значительно улучшить
качество жизни животных. Это, прежде всего,
разработка новых эффективных лекарств и биологически активных комплексов,
материалов для медицинского
использования и одежды, средств
защиты от паразитов
и по уходу за животными,
кормов и пищевых добавок, материалов для игрушек и амуниции.
Биохимический,
иммунохроматографический,
иммунофлюоресцентный
и
прочие
анализы помогают врачам ветеринарной медицины поставить
более точный диагноз и оперативно следить за ходом
лечения животных. Различные анализы проводят и в научных
целях.

На
кафедре «Химия и химические технологии»
Севастопольского государственного
университета
совместно с
одной из ветеринарных клиник города ранее были проведены
исследования
физиологических и биохимических
особенностей организма собак при наличии у них
клещевых инфекций.

А в
Институте дополнительного профессионального
образования СевГУ помогут с содержанием и
воспитанием питомцев. Там реализуются несколько
программ
повышения квалификации, связанных с послушанием и
дрессировкой собак.
Подробнее
|
 |
14 июня 2025 г.
День города Севастополя
–
города, достойного поклонения. В этом
году Севастополю исполнилось 242 года.
Немного химической летописи нашего
замечательного города.
1892 г.
Спасительная синька. В
парикмахерских и цирюльнях
Севастополя
для дезинфекции полотенец и салфеток использовался водный раствор
синьки. Так уже в те
времена население называло краситель
метиленовый синий (метиленовый
голубой, метиленовая синь).
Санитарные правила требовали обязательное наличие ведра
с синькой в этих заведениях. Парикмахерские инструменты следовало
кипятить в 1% растворе соды
(карбоната натрия
Na2CO3)
или
обрабатывать 2% раствором формальдегида. Метиленовый синий и формальдегид
являются антисептиками и до сих пор используются в
медицине.

Синька (метиленовый синий)
1924 г.
«Товарищ,
вступай в члены Доброхима!».
На Нахимовском проспекте, 21
(так раньше называли в
Севастополе проспект Нахимова)
располагалось отделение Доброхима
(Доброхим
–
Добровольное общество друзей химической обороны и
химической промышленности).
Это здание не сохранилось, сейчас на его месте находится дом №5. Общество было создано 19 мая 1924 г. и
занималось химическим просвещением населения, в том числе
и в военно-химической области. Девизом организации стала
фраза
«Массовая
защита от газов
– дело трудового народа!».
Однако
Доброхим просуществал всего лишь год и 23 мая 1925 г.
объединился с
Обществом
друзей воздушного флота под новым
названием «Авиахим».
Подробнее о химической
летописи Севастополя
|
 |
10 июня 2025 г.
Сладкий день календаря – праздник у мороженого. Есть
повод съесть мороженное, т.к. сегодня
отмечается
Международный день
мороженого.

Подробнее о
мороженом и его химическом составе
|
 |
09 июня 2025 г.
Научное шоу
"Занимательная химия". В Севастопольском
государственном университете на кафедре "Химия и
химические технологии" состоялось
научное шоу,
посвященное занимательной химии. Студенты увидели не
только зрелищные и занимательные химические опыты, но и
активно обсуждали причины происходящих процессов. Они узнали много полезной информации о металлах,
лекарствах, их влиянии на организм человека.

"Синяя колба", "Фараоновы
змеи", "Взаимодействие металлов с водой", "Свойства
крахмала", "Искусственная
кровь"
–
вот некоторые из опытов, которые были показаны на шоу. В
постановке ряда экспериментов непосредственное участие
приняли сами студенты. Мероприятие организовали доцент
кафедры Ткаченко Э.В. и профессор Яковишин
Л.А.

Подробнее о
занимательных химических опытах
|
 |
30 мая 2025 г.
Международный день картофеля.
Отмечают этот праздник
по решению Генеральной Ассамблеи ООН.
Родом
паслен клубненосный
Solanum tuberosum L. (так
еще называют известный всем картофель) из Южной Америки.
Раньше к
картофелю относились весьма скептически и называли
"чертовым яблоком", т.к. при поедании плодов и незрелых
клубней случались отравления. Не все знали, что эти
части картофеля ядовиты. Крестьяне не хотели выращивать
"земляное яблоко" и устраивали "картофельные бунты".
"Щи, хлеб и каша
–
вот пища
наша", а не какой-то заморский овощ. Но времена менялись
и "земляное яблоко раздора" все больше распространялось
по стране.

Подробнее о картофеле и его химическом составе |
 |
25
мая - День химика!
С
праздником!!!
«Я уверен, что ни один из тех,
кто заинтересуется химией, не пожалеет о том, что
выбирает эту науку в качестве своей специальности».
Н.Д. Зелинский

|
 |
17 мая 2025 г. состоялся
VII Международный химический диктант,
организованный химическим факультетом Московского
государственного университета имени М.В. Ломоносова,
группой компаний «Просвещение» и
Ассоциацией учителей и преподавателей химии. Тема
диктанта в этом году – «Формула
Победы».
Студенты
Севастопольского государственного университета
на диктанте показали хорошие результаты.
Наиболее активно участвовали в диктанте студенты
Института фундаментальной медицины и здоровьесбережения
СевГУ.

|
 |
25.04.2025
г.
Международный день
молекулы ДНК. За
этими тремя буквами (ДНК
–
это аббревиатура от названия
дезоксирибонуклеиновая
кислота)
скрывается сложнейшая химическая структура, благодаря
которой
хранится и передается генетическая
информация в живой клетке.
В этот день в 1953 г. в журнале Nature
были опубликованы 3 статьи,
посвященные молекулярной
структуре нуклеиновых кислот. В одной из них,
подготовленной
Дж. Уотсоном и Ф. Криком, была
описана двойная спираль ДНК. Поэтому
25 апреля стали отмечать как день ДНК.
Однако впервые ДНК была выделена
еще в 1869 г. двадцатипятилетним швейцарским врачом Фридрихом Мишером из лейкоцитов, содержащихся
в гное. Гнойные повязки он собирал в ближайшей больнице.
Да, чего только не сделаешь ради науки!
Полученное новое вещество
Мишер назвал
нуклеином.

Подробнее о
ДНК
|
 |
06.03.2025
г.
В этот день
в 1899 г.
был
получен патент на торговую марку «Аспирин». Аспирин
является
торговым названием
ацетилсалициловой кислоты.
Вот уже более 125 лет это лекарство помогает
людям при различных заболеваниях.

В Севастопольском
государственном университете
на кафедре "Химия и химические
технологии"
исследовали
легендарный аспирин, которому более 100 лет. Анализ,
проведенный профессором СевГУ
Л.А.
Яковишиным,
показал, что
препарат, к сожалению,
практически весь уже разложился.
Со временем
ацетилсалициловая кислота распадается на уксусную и
салициловую кислоты.
Этот процесс
ускоряется во влажной атмосфере, при нагревании и
действии УФ-света.

Но ученые
СевГУ изучили не только аспирин из прошлого.
Профессором
Л.А.
Яковишиным
были
получены новые фармацевтические композиции на основе ацетилсалициловой
кислоты, силденафила
и сапонинов плюща и солодки.
Они могут улучшить ее физико-химические и
фармакологические свойства.
Несмотря
на более чем вековой возраст, ацетилсалициловая
кислота все так же продолжает
применяться в лечебной практике и активно изучается
во всем мире.
Подробнее об аспирине
|
 |
1 марта
не только день начала весны, но и
День кошек.
Жизнь кота без химии не та!
Кошки взаимодействуют с окружающим
миром и между собой с помощью
феромонов, веществ, которые выделяют их железы.

Самоcat
Подробнее о
кошачьих феромонах
|
 |
01.03.2025
г.
В этот день
в 1773 г.
шведский химик и фармацевт
Карл Вильгельм
Шееле
(1742–1786), который является одним из
первооткрывателей кислорода,
описал опыт
по адсорбции на древесном угле. С тех пор адсорбция
нашла широкое применение в различных областях, в том
числе и медицине.
А спустя
252 года студенты
Института фундаментальной медицины и здоровьесбережения
Севастопольского
государственного университета
провели
лабораторную работу по адсорбции на активированном угле.


|
 |
28.02.2025
г.
Состоялось
награждение Почетными грамотами
студентов,
принявших активное участие в работе
Шестой региональной
научно-практической конференции
«Первые шаги в науку».
Конференция была организована
Институтом ядерной энергии и промышленности
Севастопольского
государственного университета.

Подробности
|
 |
10.02.2025
г. В Севастопольском
государственном университете
состоялась
III
Молодежная
научно-практическая конференция,
посвященная Дню
российской науки.
В
работе этого форума приняли активное участие члены
студенческого научного общества кафедры "Химия и
химические технологии" СевГУ. Они сделали доклады в
секциях естественных и социально-гуманитарных
наук.

Подробности
|
 |
08.02.2025 г.
День российской науки. Поздравляем научных
работников, преподавателей, аспирантов и студентов с
научным праздником!
Среди
лучших научных разработок
Севастопольского государственного университета за
2024 год было отмечено получение перспективных
субстанций для противоопухолевых средств, которые синтезированы на кафедре
"Химия и химические
технологии" СевГУ.

|
|
 |
 
01.01.2025 г.
Новогодняя химия.
Получение
«фараоновых змей»
Символом
наступившего 2025 года является змея.
С помощью химических реакций можно получить подобие
настоящих змей.
Это так называемые
«фараоновы змеи».
«Фараонова
змея»
представляет собой
многократно увеличивающуюся в объеме
твердую пористую массу, очень
похожую на извивающуюся змею. Опыты по их получению
– это одни
из самых зрелищных химических экспериментов.

«Химические змеи»
из глюконата кальция
В
Севастопольском
государственном университете есть свой
«химический серпентарий».
Здесь, на кафедре
«Химия и химические
технологии», уже более 20 лет
разрабатываются занимательные опыты по получению «фараоновых змей» из
доступных и безопасных средств.
Профессором
Яковишиным Л.А.
были получены
«фараоновы змеи»
из глюконата кальция и сульфаниламидных препаратов.
Со временем эти опыты стали очень популярны. Сейчас
их можно
увидеть на телевидении,
различных сайтах, научных шоу, при проведении
научных игр и т.д.

«Фараонова
змея» из сульфаниламидного препарата
Подробнее о фараоновых змеях
|


|
30.12.2024 г.
Новогодние традиции.
Немного об
истории новогодних украшений
Традиция украшать дома еловыми,
сосновыми и можжевеловыми ветками появилась у нас
325 лет назад благодаря указу царя Петра
I
№ 1736 от 20 (30) декабря 1699 г. По этому указу
новый
год в России теперь начинался не с 1
сентября, а
с 1 января. Но новогодние наряженные елки стали массово
появляться в
домах только к середине XIX
века.
Раньше елочные украшения были в
основном съедобными, т.е. являлись и украшением, и
угощением. На елки
вешали яблоки, мандарины, орехи, конфеты и
фигурные пряники. Наряжали елки также тканями, бумагой, цветами
и, конечно же, восковыми свечами. Позже появились
украшения из стекла, металла и ваты. С
развитием стекольной промышленности стали производить не
только стеклянные шары разных размеров и цветов, но и
разной формы. Блеск шарам придавал тонкий слой свинца,
который наносился с внутренней стороны. Потом для
получения блеска стали использовать серебро.

Подробнее о
новогодних традициях
|
|

 |
28.12.2024 г.
В этот день
исполняется 155 лет одному из
прообразов современных жвачек на основе каучука
28 декабря 1869 г. американский дантист
Уильям Финли
Семпл (1832–1923)
из
штата
Огайо
получил патент «Улучшенная жевательная резинка» на изготовление жвачки на основе каучука. К его раствору
в лигроине и спирте добавлялся мел и измельченный корень
солодки. В качестве альтернативных размягчителей каучука
Семпл также предлагал использовать спермацет, парафин,
воск и прочие компоненты. По его мнению
еще в жвачку можно было
добавлять древесный уголь, сахар, корень ириса и даже
барит (минерал, представляющий собой сульфат бария
BaSO4).
Семпл считал, что его жвачка также будет хорошим
средством для
чистки зубов.

Подробнее о
жевательной резинке
|
|

 |
7.12.2024
г. в
Институте ядерной энергии и промышленности
Севастопольского
государственного университета
состоялась
Шестая региональная
научно-практическая конференция студентов и школьников
«Первые шаги в науку».
О своих научных
достижениях рассказали члены студенческого научного общества,
организованного на кафедре «Химия и химические
технологии» СевГУ.
Подробности
|
|

 |
21–22 ноября 2024
г. в Уфимском университете науки и технологий проходила
VIII Всероссийская
молодежная конференция «Проблемы и достижения химии
кислород- и азотсодержащих биологически активных
соединений». Своими достижениями
поделились молодые ученые из Москвы, Санкт-Петербурга,
Уфы, Казани и других городов. Среди участников были и
зарубежные представители. Сборник тезисов докладов
участников конференции будет размещен в РИНЦ.
На конференции был
представлен доклад студента 2 курса
Института фундаментальной медицины и здоровьесбережения
Севастопольского
государственного университета Рожко
Артема. Свои исследования, посвященные
фармацевтическому анализу препарата плюща, он провел в лаборатории
кафедры «Химия и химические
технологии» (научный руководитель профессор Яковишин Л.А.).

|
|

 |
22.10.2024
г. О результатах
научной работы
преподавателей кафедры «Химия и химические
технологии» Севастопольского
государственного университета
рассказано в
программе "Актуальное
интервью" на телеканале НТС.

|
|

 |
7-12 октября 2024
г. на федеральной территории
«Сириус»
проходил ХХII Менделеевский
съезд по общей и прикладной химии.
Среди организаторов этого химического форума были
Российская академия наук,
Российское химическое общество имени Д.И. Менделеева,
Министерство науки и высшего образования, ФТ
«Сириус»
и университет «Сириус».
Съезд
состоялся под эгидой
IUPAC (Международного союза теоретической и прокладной химии)
и был посвящен 300-летию РАН и 190-летию Д.И.
Менделеева.

На съезде были представлены данные
о новых противоопухолевых субстанциях,
синтезированных на кафедре «Химия и химические
технологии»
Севастопольского
государственного университета. Исследование
полученных веществ проведено совместно с Уфимским федеральным
исследовательским центром РАН и
Крымским федеральным
университетом имени В.И. Вернадского.
|

 |
11.10.2024
г. Всемирный
день яйца. Этот праздник не имеет фиксированной
даты и отмечается по решению Международной яичной
комиссии во вторую пятницу октября.
Яйца содержат белки, жиры, витамины и
другие полезные вещества. В них найдено более 35 химических элементов.
Поэтому яйца являются очень важным продуктом питания.
Ну а мы предлагаем вам заняться
"яичной химией" и провести цветную реакцию на
белок –
биуретовую реакцию.
|
|


|
25 сентября 2024 г.
Международный день фармацевта. Этот
праздник отмечают провизоры и фармацевты, а также все,
кто связан с производством и разработкой лекарственных
средств.
Ученые Севастопольского
государственного университета тоже занимаются
созданием перспективных фармацевтических субстанций и
изучением механизмов их действия. Доктор химических
наук, профессор кафедры «Химия и химические
технологии» СевГУ Л.А. Яковишин недавно
синтезировал новые противоопухолевые фармацевтические
субстанции на основе 5-фторурацила и природных
соединений. Исследование полученных субстанций проведено
совместно с учеными Уфимского федерального
исследовательского центра Российской Академии наук и
Крымского федерального
университета имени В.И. Вернадского.

5-Фторурацил
5-Фторурацил
относится к антиметаболитам. Он встраивается в
молекулу РНК, подменяя естественное азотистое основание
урацил, в результате чего изменяются ее свойства. Кроме
того, он также нарушает синтез ДНК за счет ингибирования
одного из ферментов. Так подавляется деление опухолевых
клеток. Препарат назначается при
лечении рака пищевода, желудка, толстой и прямой кишки, молочной
железы, яичников, печени и поджелудочной железы. Однако он
обладает высокой токсичностью и может оказать побочное
действие на организм человека.

Одно из полученных в СевГУ соединений
оказалось достаточно активно в отношении клеток нейробластомы человека и аденокарциномы протоков
молочной железы человека. Нейробластома – опухоль, часто
встречающаяся у детей. Действие данной субстанции
сопоставимо с активностью известных противоопухолевых
лекарственных препаратов, но содержит уменьшенное
количество 5-фторурацила.
Результаты этого исследования
опубликованы в журнале «Известия
Академии наук. Серия химическая» («Russian
Chemical Bulletin»).
|
|

 |
23 сентября 2024 г.
День
рождения жевательной резинки.
Сегодня жевательная резинка – это одно из самых
распространенных кондитерских изделий.
Прототипы
современных жвачек появились очень давно. Что только не
жевали люди в разные времена. Еще несколько тысяч лет
назад жители Центральной Америки (индейцы) жевали
натуральный каучук. Люди жевали также смолу и кору
деревьев, парафин с добавкой сахара, пчелиный воск и
даже смесь листьев и семян с добавкой извести.

Выделение камеди на дереве
В
этот день в 1848 г. 21-летний американец Джон Бэкон
Кертис (1827–1897) приготовил в домашних условиях
жвачку на основе еловой смолы. Для этого он нагрел ее в
горшке своей жены, затем вылил в холодную воду и
отфильтровал. С этого события началось первое
коммерческое производство жвачки. Свою жвачку он назвал
«Чистая еловая резинка штата Мэн». В 1850 г. Кертис стал
выпускать парафиновые жвачки с добавлением сахарозы и
ароматизаторов. Вместе с отцом он основал компанию «Curtis
& Son». В 1852 г.
они открыли фабрику по производству жвачки.

На
кафедре «Химия и химические технологии» Севастопольского государственного университета
разработаны методики проведения экспериментов с
жевательными резинками для использования в учебных
заведениях. Они включают
химические опыты с резиновой
основой и прочими компонентами жевательных резинок.
Подробнее о
жевательной резинке
|

 |
1 августа 2024 г. В этот
день 250 лет назад
был впервые получен молекулярный кислород.
Процесс осуществил английский химик
Джозеф
Пристли (1733–1804). Он получил кислород
реакцией разложения оксида ртути(II),
который нагревал с помощью солнечного света,
сфокусированного линзой большого диаметра:
2HgO ® 2Hg
+ O2↑

Д. Пристли назвал
кислород "дефлогистированным воздухом". Проводя
свои эксперименты, он обнаружил, что в этом газе ярко горит
свеча и может жить мышь. Однако некоторые ученые
оспаривают приоритет открытия кислорода Д. Пристли.

Опыт Д. Пристли по получению кислорода
·
Как получить
кислород. Джозеф Пристли получил кислород из
токсичного оксида ртути(II).
Безопасным источником кислорода является пероксид
водорода Н2О2 в виде 3%
раствора, который имеется практически в каждой домашней
аптечке. Достаточно к нему добавить катализатор, и
пероксид разложится на кислород и воду:
2H2O2
® 2H2O
+ O2↑
В качестве
источников катализатора можно взять кусочек свежего мяса
(содержит фермент каталазу) или ржавый гвоздь.
·
Разноцветный
кислород. Все знают, что кислород
–
это бесцветный газ. Но в жидком и
твердом состоянии он светло-голубой. При очень
большом давлении (миллиарды Па) кислород может быть
оранжевым, красным, черным и даже металлическим.

Л.А. Яковишин |

 |
17.07.2024 г.
Об исследовании легендарного
препарата прошлого Спермина Пеля
на кафедре "Химия и химические технологии"
Севастопольского государственного университета
рассказано в
сюжете на канале "Крым24".
Подробнее о
Спермине Пеля
|

 |
14 июня (3 июня по старому
стилю) 2024 г. отмечается
День города Севастополя
–
города, достойного поклонения. В этом
году Севастополю исполнился 241 год.

Дворец
детского и юношеского творчества в Севастополе
Немного химической летописи нашего
замечательного города. В 1913 г.
в Севастополе на
Нахимовском проспекте, 9 (сейчас проспект Нахимова)
функционировала врачебно-диагностическая, техническая и химическая
лаборатория, в которой был химиком младший
ординатор Севастопольского морского госпиталя Валериан
Валерианович Лютинский (Лютынский).
Это здание не сохранилось. Располагалось оно напротив
Романовского Института физических методов лечения (сейчас Дворец
детского и юношеского творчества). В
лаборатории проводились анализы крови, санитарные и
химические исследования.

Фонтан у
Дворца детского и юношеского творчества.
На месте
нынешнего дома №1 на проспекте Нахимова (дом за
фонтаном) располагался дом №9, в котором функционировала
врачебно-диагностическая, техническая и химическая
лаборатория
В это
время в городе
также работали
химико-бактериологические кабинеты.
Один из них старшего
ординатора и прозектора Севастопольского морского
госпиталя Василия Флегонтовича Аристова
размещался на Екатерининской, 59 (ныне
улица Ленина).
Сейчас на месте этого дома находится часть сквера
воинов-интернационалистов. Химико-бактериологический
кабинет провизора Александра Иустиновича Отрашкевича
был на Большой
Морской, 12.
Кроме того,
химическая лаборатория
существовала и в Севастопольском порту. Химиком в
ней был надворный советник Сумотчиков
Алексей Иванович. Он известен еще тем, что являлся
гласным Севастопольской городской думы
и
помогал в
Санкт-Петербурге великому химику Дмитрию Ивановичу Менделееву с измерениями срезов
деревьев, полученных в экспедиции на Урал в 1899 г.
Целью этой экспедиции было исследование уральской
железодеятельной и горнозаводской промышленности.
Л.А. Яковишин |

 |
1 июня (13 июня по новому
стилю) 2024 г. исполняется
135 лет органотерапии.
Органотерапия – это
метод лечения, основанный на использовании тканей и
органов животных, а также извлечений из них.
1 июня 1889 г. французский медик
профессор
Шарль Эдуар Броун-Секар
(1817–1894) на заседании Биологического общества
в Париже сделал сенсационное заявление о возможности
омоложения с помощью подкожных инъекций извлечений из
яичек морских свинок и собак. Опыты он проводил на себе
и животных. Поэтому этот день стали считать датой
основания органотерапии.
Впоследствии
органопрепараты стали использоваться по всему миру.
Применяются они при лечении ряда заболеваний и в
настоящее время.
Это, например, панкреатин
–
препарат, полученный из поджелудочных
желез животных (свиней и крупного рогатого скота). Он
содержит различные пищеварительные ферменты.
В конце XIX в. в России профессором
Александром Васильевичем Пелем
(1850–1908) был разработан лекарственный органопрепарат
Спермин Пеля (Spermini-Poehl). Он выпускался Органотерапевтическим институтом профессора
доктора Пеля и сыновей (г. Санкт-Петербург) и был практически
единственным российским лекарственным средством, которое
экспортировалось в конце XIX – начале
XX веков.
Спермин Пеля назначался
практически от всех
болезней, поэтому он был очень популярен.
В 1914 г. в
Севастополе флакон капель Спермина Пеля можно было купить за 2 руб. 50
к.

Флакон
препарата Спермин Пеля капли
На кафедре «Химия и химические технологии»
Севастопольского государственного университета
разрабатываются не только новые фармацевтические
субстанции, но и изучаются лекарства прошлого.
Недавно профессором
СевГУ Л.А.
Яковишиным был проведен анализ
Спермина Пеля – чудодейственного «лекарства от всех болезней».
Исследование подтвердило наличие
действующего вещества
– гидрохлорида спермина, несмотря на внушительный
возраст препарата. Ему около 110–130
лет.
Сохранность активного компонента лекарства обусловлена
его солеобразной природой и герметичностью упаковки.
Л.А. Яковишин
Подробнее о
Спермине Пеля |
|

 |
12.06.2024 г.
В
Севастопольском государственном университете
идет зачетно-экзаменационная сессия.
"Правило Морковкина",
"Ломоносов шел с арбузом из Архангельска в
Москву",
"Самый распространенный
химический элемент в космосе
–
это звезды"
и
"Номенклатура
органических соединений ИЮФАК"
–
вот немногие перлы из ответов студентов на экзаменах и
зачетах по химии. Познакомиться с последними
студенческими "шедеврами" можно в разделе
"Спецюмор
на СевХимПортале".

На
экзамене по химии

Эволюция
студенческих шпаргалок
|

 |
26
мая - День химика!
С
праздником!!!

|
|

 |
18 мая 2024 г. состоялся
VI Международный химический диктант,
организованный химическим факультетом Московского
государственного университета имени М.В. Ломоносова,
группой компаний «Просвещение» и
Ассоциацией учителей и преподавателей химии. Тема
диктанта в этом году – «Химия вокруг
нас».


Студенты
Института фундаментальной медицины и здоровьесбережения СевГУ
Студенты Института фундаментальной медицины и
здоровьесбережения,
Гуманитарно-педагогического
института и Института перспективных исследований
Севастопольского государственного университета
приняли активное участие в этом
мероприятии и показали хорошие результаты. Некоторые из
них получили максимальный балл.

Студенты
Гуманитарно-педагогического института СевГУ
|
|

 |
12.04.2024 г. На
кафедре «Химия и химические технологии» Севастопольского
государственного университета были синтезированы
новые фармацевтические субстанции
на основе супрамолекулярных
комплексов растительного
сапонина солодки и фторхинолоновых антибиотиков.
Для этого использовали ципрофлоксацин и
норфлоксацин (фторхинолоны
второго поколения) и моксифлоксацин (антибиотик
четвертого поколения), а также их
производные.

Моксифлоксацин
Фторхинолоновые
антибиотики широко применяются в медицинской практике
при инфекциях мочевых и дыхательных путей, уха, горла,
носа, кожи, почек, при остеомиелите и
перитоните.
В последнее время отмечается устойчивость
микроорганизмов к ряду антибиотиков. Поэтому поиск новых
антимикробных препаратов является актуальной задачей
современной фармацевтики.
Исследование
полученных субстанций проведено совместно с учеными Казанского национального исследовательского
технологического университета, Казанского (Приволжского)
федерального университета и Института
органической и физической химии им. А.Е. Арбузова
ФИЦ «Казанский научный центр РАН».
«Сотрудничество с
казанскими коллегами мы начали еще в 2018 г. Недавно
было завершено биологическое тестирование
синтезированных нами субстанций. Оно показало, что
некоторые из них сравнимы по антибактериальной
активности с индивидуальными фторхинолоновыми
антибиотиками или превосходят их в отношении ряда
бактерий. Но наши субстанции содержат в 2 раза меньше
антибиотиков. Это позволяет рассматривать
их в качестве перспективных
низкодозных антимикробных лекарственных средств», –
рассказал доктор химических наук, профессор кафедры «Химия
и химические технологии» СевГУ Л.А.
Яковишин.

Результаты
исследования опубликованы в журнале
Current Bioactive Compounds.
|
|

 |
06.03.2024
г.
125 лет торговой марке
«Аспирин».
6 марта 1899 г.
был
получен патент на торговую марку «Аспирин». Аспирин
является
торговым названием
ацетилсалициловой кислоты.
Вот уже 125 лет это лекарство помогает
людям при высокой
температуре, боли, воспалительных и сердечно-сосудистых
заболеваниях. Установлено, что ацетилсалициловая кислота
может снижать риск возникновения некоторых видов рака.
Отмечалось снижение риска смертности от COVID-19
при раннем назначении аспирина.

Подробнее об аспирине
|
|

 |
15.02.2024 г.
Количество просмотров страниц СевХимПортала составило
2
000
000.
 |


|
18.12.2023
г.
исполняется
60 лет
со дня организации на базе Севастопольского филиала
Одесского политехнического института Севастопольского
приборостроительного института (СПИ).

На
лабораторном занятии по химии в СПИ
Химическая
фотолетопись СПИ
|

 |
22.09.2023
г.
Новейшая история Севастополя и Севастопольского
государственного университета.
Состоялась
первая лекция по химии для студентов нового для
СевГУ
направления подготовки "Лечебное дело". В этом
году
в Севастополе
впервые
началась подготовка врачей. При этом химические
дисциплины играют важную роль в системе подготовки
будущих медицинских работников.

Будущие
врачи на лекции по химии
Подробности
|
|

 |
11-15.09.2023
г.
В Севастопольском государственном университете проходит
XVIII
Международная научная конференция "Актуальные вопросы
биологической физики и химии. БФФХ-2023".
Тематические направления этого научного форума включают
вопросы медицинской биофизики и биофизической химии.
В
работе конференции приняли участие ученые из Московского
государственного университета им. М.В. Ломоносова,
Севастопольского государственного университета,
Воронежского государственного университета, Института
молекулярной биологии им. В.А. Энгельгардта РАН,
Южно-Уральского государственного университета,
Российского университета дружбы народов, Российского
научного центра рентгенорадиологии, Института биологии
южных морей им. А.О. Ковалевского РАН, Никитского
ботанического сада – Национального научного центра РАН,
Ивановского государственного химико-технологического
университета, Института биохимической физики им. Н.М.
Эмануэля РАН, Федерального исследовательского центра
химической физики им. Н.Н. Семенова РАН, Московского
педагогического государственного университета,
Московского государственного медико-стоматологического
университета им. А.И. Евдокимова, Института общей и
неорганической химии им. Н.С. Курнакова РАН, Первого
Московского государственного медицинского университета
им. И.М. Сеченова и других организаций.

|
|

 |
06.03.2023
г.
День рождения торговой марки
«Аспирин».
6 марта 1899 г.
был
получен патент на торговую марку «Аспирин». Аспирин
является
торговым названием
ацетилсалициловой кислоты.
Первые публикации об ацетилсалициловой кислоте появились
еще 170 лет назад.
Подробнее об аспирине
Познакомиться
с историей синтеза ацетилсалициловой кислоты, разработкой препарата аспирин,
появлением его в России, становлением выпуска
отечественного аспирина в период Первой мировой войны, а
еще узнать основные
направления современных исследований ацетилсалициловой кислоты
можно также
в следующей статье:
Яковишин Л.А. Ацетилсалициловая кислота: история
получения и современное использование // Ученые записки
Крымского федерального университета имени В.И.
Вернадского. Биология. Химия. – 2022. – Т. 8 (74), №
4. – С. 304–323.

|

 |
4 марта отмечается
Всемирный день инженерии.
Получить инженерную специальность можно в
Институте
ядерной энергии и промышленности
Севастопольского государственного университета.
Институт занимается подготовкой
специалистов в области:
- атомной
энергетики и промышленности,
- систем
энергоснабжения,
- холодильного
оборудования,
- химической
технологии,
- охраны
окружающей среды,
-
энергосберегающих технологий,
- природообустройства
и водопользования.

|
|

 |
1 марта
начинается весна и отмечается
День кошек. Жизнь кота без химии не та!
И это действительно так, ведь кошки взаимодействуют с окружающим
миром с помощью смесей различных веществ
–
феромонов, которые выделяют их железы. Выделяя свои и анализируя феромоны собратьев, кошки
осуществляют химическую
коммуникацию.


Подробнее о
кошачьих феромонах
|
|

 |
08.02.2023 г.
День российской науки. Поздравляем научных
работников, преподавателей, аспирантов и студентов с
праздником!
Преподаватели
кафедры "Химия и химические технологии"
Севастопольского государственного университета
синтезируют новые фармацевтические субстанции,
занимаются вопросами коррозии, водоподготовки и
адсорбции, получают композиционные материалы,
моделируют технологические процессы, модифицируют
сорбенты, осуществляют радиационный мониторинг изотопов
различных элементов, проводят исследования в области
методики преподавания химии в школах и высших учебных
заведениях.
|
 |
8
февраля родился великий русский
химик Дмитрий Иванович Менделеев (1834–1907),
всем известный как создатель Периодического
закона и Периодической системы химических
элементов. |
|
|

 |
06.02.2023 г.
Количество просмотров СевХимПортала составило
более
1
900
000.

|
|

 |
16
января
2023
г.
отмечается
День ледовара.
Ледовары готовят лед для различных площадок и спортивных
сооружений.

Льдом и снегом покрыто
20% поверхности нашей планеты
Лед
издавна используют для
охлаждения продуктов и лекарств. Из него изготавливают
скульптуры и строят различные сооружения.
Сначала лед заготавливали, используя природные
источники, а затем стали получать искусственно.

При охлаждении до 0°С вода образует прозрачные кристаллы
льда. В переводе с греческого
krystallos
означает «лед». Плотность обычного льда (модификация
Ih)
составляет 0,917 г/см3, т.е. он легче воды, и
поэтому плавает на ее поверхности. Это аномальное
свойство объясняется существованием водородных связей. В
кристаллах льда каждая молекула воды образует такие
химические связи с четырьмя другими молекулами. Длина
водородных связей около 0,28 нм. Водородные связи имеют
тетраэдрическую направленность. В результате
у льда формируется ажурная
кристаллическая решетка.

·
В корабле моем опилки…
.
Во время Второй мировой войны в Англии был разработан
проект авианосца «Хабаккук» («Habakkuk»),
который первоначально хотели изготовить из айсберга, а
потом – из смеси льда и древесных опилок. Автором
проекта был Джеффри Пайк. В его честь
композиционный материал изо льда (86 %)
и опилок (14 %)
назвали пайкеритом. В Канаде был сделан уменьшенный
прототип такого судна, однако проект так и не был
реализован. Его закрыли в 1943 г.
·
Лед в первом российском небоскребе.
В начале 1900-х г. в Севастополе существовала фабрика
искусственного льда. Располагалась она в подвальном
этаже дома Анненкова, построенном в 1902 г. Это
семиэтажное железобетонное здание считают первым небоскребом в России.
В подвале дома также находился большой ледник.
Ле́дник
– это помещение для хранения продуктов, охлаждение
которого осуществляется льдом.

Дом Анненкова
в Севастополе - первый небоскреб в России
(сейчас – здание ГУМ на
ул. Маяковского, 8 в Севастополе;
фото 2006 г.)
Л.А. Яковишин
Подробнее о льде |
|

 |
17-18
ноября 2022
г.
в
Уфимском университете
науки и технологий прошла
VI Всероссийская молодежная конференция «Проблемы и
достижения химии кислород- и азотсодержащих биологически
активных соединений». Уфа
является крупным научным центром России.
В работе
конференции приняли участие 355 человек
из 23 городов России и ближнего зарубежья.
Аспирант 1 года обучения кафедры «Физика»
Севастопольского государственного
университета Владимир Ратников
(научный руководитель д.х.н., проф.
Яковишин Л.А.) выступил с докладом
на этом научном форуме и получил
диплом
II
степени.

Об
этом событии нам рассказал призер
конференции Владимир Ратников:
«Это было мое
первое участие в профильной конференции такого высокого уровня. Я делал доклад о
новом супрамолекулярном комплексе антиоксиданта рутина и
его биологической активности. Такие комплексы являются
перспективными для фармацевтики. На конференции было
много докладов по комплексам разных веществ, что
подчеркивает актуальность наших исследований и
соответствие их современным тенденциям в данной научной
области.
На
конференции была дружественная и приятная атмосфера.
Я ощутил себя среди единомышленников».
|
|

 |
01.11.2022 г.
День уксуса. Этот
праздник первоначально появился в США, но потом стал
отмечаться и в других странах.

Во всем мире широко используют уксус – приправу на основе
уксусной кислоты
СН3СООН. Уксус был известен с древних
времен. На Ближнем Востоке его получали из фиников еще 7000 лет назад. Древнегреческий врач и философ
Гиппократ (ок. 460 г. до н.э. – ок. 370 г. до н.э.)
советовал использовать уксус для обработки ран и лечения
кашля.
Людей, которые изготавливали или продавали уксус,
раньше называли уксусниками. Уксусником также
именовали сосуд, в котором получали уксус, продавали его
или подавали на стол.
Еще в царской России
концентрированную уксусную кислоту (уксусную эссенцию)
продавали
в
аптеках и аптечных магазинах
в трехгранных бутылочках, которые нельзя было
перепутать ни с какими другими. Существовали уксусники и
четырехгранные из обычного или синего стекла. Уксусники были
рассчитаны на приготовление определенного числа бутылок
крепкого столового уксуса. Растворением 1 меры уксусной
эссенции в кипяченой воде («отварной воде»), взятой
объемом с одну винную бутылку, получался столовый уксус.
При необходимости его разбавляли еще в 2 раза.

Уксусники
XIX–XX вв.
("Мѣра на 1 бутылку" и "Мѣра на 2
бутылки")
Уксус был не только приправой. Раньше он являлся еще и
доступным лекарственным средством. Его широко
использовали в качестве антисептика. Им
протирали кожу, раны, предметы, а также
применяли для окуривания помещений. Уксусом обрабатывали раны во время Первой
обороны Севастополя (1854–1855
гг.).
Интересен рецепт так называемого
уксуса четырех
разбойников или четырех воров (XVIII в.). Такой
уксус настаивался на шалфее, руте, мяте, полыни и лаванде.
К нему добавляли еще камфору. Считалось, что он
может спасти даже от «морового
поветрия»
(эпидемии с высокой смертностью). В XVIII в. этот уксус
продавался в европейских и российских аптеках. Уксус
четырех воров можно купить в настоящее время, но не как
лекарство. Он до сих пор выпускается за рубежом и в
России.
Был придуман даже
сухой уксус в виде таблеток. Он
состоял из ацетата натрия СН3COONa
(соли
уксусной кислоты), лимонной кислоты и сахара. Если
поместить такую таблетку в воду, то происходит
растворение ее компонентов, и между ацетатом натрия и
лимонной кислотой наблюдается реакция с
образованием уксусной кислоты. Сахар придавал такому
уксусу особый вкус.
В
таблетку могли быть включены дополнительные компоненты (красители
и
вкусовые добавки), улучшающие цвет, вкус и аромат получаемого
уксуса.
Л.А. Яковишин
Подробнее об уксусной кислоте и
уксусе |

 |
25 октября
2022
г. отмечает юбилей
кандидат химических наук, доцент кафедры «Химия
и химические технологии» Севастопольского
государственного университета Толстенко Юлия Викторовна.

Уважаемая Юлия Викторовна!
Коллектив кафедры
«Химия и химические технологии»
СевГУ
сердечно поздравляет Вас с юбилеем.
Желаем Вам
крепкого здоровья, отличного настроения,
счастья, благополучия, успехов в научной и методической деятельности!
 |
|

 |
24.06.2022
г.
на кафедре "Физика" СевГУ состоялась защита выпускных
квалификационных работ у магистров направления подготовки "Физика" (профиль
"Биофизика"). Все студенты показали отличные результаты.
Поздравляем с успешной защитой Бажан Полину и Ратникова Владимира.
Свои дипломные
работы, посвященные молекулярным комплексам тритерпеновых
гликозидов с биологически активными веществами, они выполнили в
лаборатории
биоорганической, биофизической и медицинской химии
кафедры "Химия и химические технологии" (научный руководитель проф.
Яковишин Л.А.).



|
|

 |
29
мая - День химика!
С
праздником!!!
"В химии все возможно"
(А. Вюрц)

У химиков
есть не только лаборатории. В некоторых городах для них
строят даже дворцы!

Дворец
химиков в Казани
|
|

 |
16-19
мая 2022 г.
в Волгограде состоялась
5-я Российская конференция по медицинской химии с
международным участием «МедХим – Россия» («MedChem
–
Russia»).
Среди организаторов конференции были
Министерство науки и высшего образования Российской
Федерации, Министерство здравоохранения Российской
Федерации, РАН, РФФИ, Волгоградский государственный
медицинский университет, Волгоградский государственный
технический университет, Московский государственный
университет имени М.В. Ломоносова и Институт
физиологически активных веществ РАН.
Профессор
кафедры
«Химия и химические технологии»
Севастопольского государственного
университета
Яковишин Л.А. представил на конференции
результаты
использования
ИК-Фурье-спектроскопии для анализа лекарственных
препаратов на основе листьев эвкалипта.
Эвкалипт
–
официнальное лекарственное растение. Разработанные на
его основе препараты (например, известный хлорофиллипт)
широко используются в качестве антибактериальных и
противовоспалительных средств.

|
|

 |
16-19
мая 2022 г.
в Севастопольском государственном университете
прошел заключительный этап
межрегиональной многопрофильной олимпиады для школьников
«Морской старт». Олимпиада проводилась в
два этапа (заочный и очный), в которых приняло участие
более 1000 школьников со всей страны. Для ребят
организаторы приготовили обширную программу. Школьники
познакомились с ведущими учеными СевГУ, посетили
различные научные лаборатории и учебный корпус в
п. Голландия.
Одно из направлений
олимпиады, которое называется
«Зеленая
планета»,
включало задания по химии и биологии. Оно ориентировано
для школьников, планирующих в дальнейшем обучение в
Институте ядерной энергии и промышленности СевГУ на
направлениях подготовки
18.03.01 Химическая технология,
05.03.06 Экология и природопользование и
20.03.02 Природообустройство и водопользование.

|
|

 |
14 мая 2022 г. состоялся
IV Всероссийский химический диктант,
организованный химическим факультетом Московского
государственного университета имени М.В. Ломоносова,
группой компаний «Просвещение» и
ассоциацией учителей и преподавателей химии. Тема
диктанта в этом году – «Химия – свет науки через стекло
жизни».

Об
этом событии нам рассказала член ФУМО, доцент кафедры «Химия и химические технологии» СевГУ, к.х.н.
Корж Елена Николаевна:
«Это мероприятие, ставшее международным, объединило
вокруг себя более 166000 участников из 71 одной страны
мира. Сохраняя традицию, в этом году в химическом
диктанте от Севастопольского государственного
университета приняли участие студенты первого, второго и
третьего курсов. Это Марсов П.
(гр. ПГС/б-21-1-о), Власовец Е.
(гр. Ф/б-20-1-о), Гладыш М.
(гр. Ф/б-20-1-о), Омелькова
Е. (гр. Ф/б-20-1-о) и
Журавлёва А. (гр. Ф/б-19-1-о)».

Самым юным
среди
участников из Севастополя
стал ученик третьего класса СОШ №22
Безусов Сергей. Он уже третий год принимает участие
в химическом диктанте. Как и в предыдущие годы, в этом
году
Сергей продемонстрировал хорошие результаты.
|
|

 |
04.05.2022 г.
исполнилось 195 лет со дня
открытия первой аптеки в Севастополе.
16 (4) мая 1827 г. на ул. Большая Морская открылась
первая аптека в городе Севастополе. В память об этом
событии 15 мая 1977 г. на фасаде дома № 48 слева от
входа в аптеку № 98 была размещена мемориальная
доска из белого мрамора. Кроме
того, к 150-летию со дня открытия первой аптеки был
выпущен памятный знак.


Большая Морская д. 48 |
|

 |
19.04.2022 г.
Одним из известных символов весны является подснежник
(галантус). У этого многолетнего
луковичного растения есть даже свой праздник – 19 апреля
отмечается День подснежника.
Он был учрежден в 1984 г. в Англии. Это праздник всех
галантофилов. Так называют поклонников подснежников,
ведь их выращивают и как декоративные растения.

Род подснежник Galanthus L.
относится к семейству амариллисовых (Amaryllidaceae
J.St.-Hil.). К этому семейству принадлежат нарциссы и
даже всем знакомые лук репчатый и чеснок.
Растения семейства амариллисовых
содержат алкалоиды (так называемые амариллисовые алкалоиды). И подснежники – не
исключение. Из них выделено более 50 алкалоидов.

Главным подснежным алкалоидом
является галантамин. Галантамин был впервые
выделен советскими учеными Проскурниной Н.Ф. и Яковлевой А.П. из луковиц
подснежника Воронова Galanthus woronowii Losinsk.,
о чем сообщалось в «Журнале общей химии» (1952 г.).
Подробнее о подснежниках и их химическом составе |
|

 |
06.03.2022
г.
День рождения торговой марки
«Аспирин».
6 марта 1899 г.
немецкой компанией
«Friderich Bayer & Co»
был
получен патент на торговую марку «Аспирин»
от
Императорского
патентного ведомства
в Берлине. Аспирин – это
торговое название
ацетилсалициловой кислоты.
Слово «аспирин» происходит от латинского названия растения
таволга (лабазник, спирея) Spiraea ulmaria, из
цветков которой
в 1835 г.
немецкий химик
Карл Якоб Ловиг
(1803–1890)
выделил салициловую кислоту.
Он назвал ее spirsäure (в
переводе с
немецкого
säure
означает «кислота»).
К части слова «spir» впереди добавили «а» от «ацетил» и
окончание «ин», характерное для многих названий лекарств.
Так появилось слово, знакомое всем уже более ста лет.


Ацетилсалициловая
кислота до сих пор активно изучается во всем мире. Не
обошли ее вниманием и ученые Севастопольского
государственного университета.
На кафедре «Химия и химические
технологии» в
лаборатории биоорганической, биофизической и медицинской
химии ими были получены фармацевтические
композиции ацетилсалициловой кислоты с силденафилом и
тритерпеновыми гликозидами плюща
и солодки. Результаты исследований были
опубликованы в
«Ученых записках Крымского
федерального университета имени В.И. Вернадского. Биология. Химия»
и
«Журнале
органической и фармацевтической химии».
Подробнее об аспирине
|
|


|
11.02.2022 г.
Международный день женщин и
девочек в науке. Он проводится по решению
ООН с целью более широкого вовлечения женщин и девочек в
научную деятельность.
В Севастопольском государственном
университете работают преподаватели-женщины, имеющие
ученые степени кандидатов химических наук по следующим
научным специальностям:
|
 |
02.00.01 – неорганическая химия |
|
02.00.02 – аналитическая химия |
|
02.00.04 – физическая химия |
|
05.17.07 – химическая технология
топлива |
Пожелаем им новых
достижений в научной работе!
|
|

 |
08.02.2022 г.
День российской науки. Поздравляем научных
работников, преподавателей и студентов с
праздником! Желаем новых научных открытий и разработок!

|
|

 |
07.02.2022 г.
Магистранты СевГУ получили
новые фармацевтические композиции
на основе рутина.

На кафедре «Химия и химические
технологии» Севастопольского
государственного университета в
лаборатории биоорганической, биофизической и медицинской
химии под руководством доктора химических наук,
профессора Л.А.
Яковишина активно развивается научное
направление, связанное с поиском новых перспективных
фармацевтических субстанций на основе
растительных гликозидов. В этой лаборатории
студенты впервые получили фармацевтические
композиции, относящиеся к новому типу молекулярных
комплексов,
включающих тритерпеновые и фенольные гликозиды.
Они рассказали нам об этом событии.

Рутин
Владимир
Ратников, магистрант 2 курса кафедры «Физика»:
«В лаборатории мы получили новые
фармацевтические композиции, содержащие
рутин. Это вещество желтого цвета называют
еще витамином P. Мы проводим ИК- и УФ-анализ, определяем
термодинамические параметры, а также оцениваем
биологическую активность. С физико-химической точки
зрения мы видим, как образуются связи между действующими
веществами на молекулярном уровне, а с биологической мы
можем оценить потенциальный эффект комплексообразования
на организм».

Полина
Бажан, магистрант 2 курса кафедры «Физика»:
«Рутин является антиоксидантом,
он укрепляем капилляры, предотвращает тромбоз.
Предварительные испытания показали, что некоторые из
полученных композиций обладают высокой антиоксидантной
активностью. Наши результаты могут послужить вкладом в
создание перспективных лекарственных средств. Также мы
проводим качественный и количественный анализ содержания
действующих веществ в различных лекарственных средствах
и биологически активных добавках».

Л.А.
Яковишин, профессор кафедры «Химия и
химические технологии»:
«В нашей лаборатории Владимир и
Полина начали заниматься научной работой еще с третьего
курса бакалавриата и к настоящему времени достигли
отличных результатов. Например, в начале этого года с их
участием вышла статья в международном научном журнале
Chimica Techno Acta, входящем в базу данных Scopus. Это
уже их вторая публикация, индексирующаяся в этой базе.
Кроме того, Владимир и Полина являются соавторами еще 4
статей в журнале из списка ВАК и участниками различных
международных конференций. Приглашаем в нашу лабораторию
студентов СевГУ, желающих заниматься перспективным
научным направлением!».
Chimica Techno Acta – это международный журнал
открытого доступа, посвященный прикладным аспектам химии
и материаловедения. Журнал индексируется Scopus, CAS,
Google Scholar, DOAJ, РИНЦ и др. базами данных.
|
|

 |
04.02.2022 г. проводится
Всемирный день борьбы против
рака (World
Cancer Day),
организованный по инициативе
Международного союза по борьбе с раком
(Union
for International Cancer Control,
URIC). Данный союз
сейчас объединяет более тысячи организаций из 172 стран.
В этот день во всем мире стремятся привлечь внимание
населения к причинам возникновения, диагностике,
лечению и профилактике онкологических заболеваний,
которые являются глобальной проблемой человечества.

Доксорубицин
Для
лечения онкологических заболеваний широко применяют
антрациклиновые антибиотики. К ним относится доксорубицин. Он обладает высокой противоопухолевой
и противолейкозной активностью, но его применение, как и
прочих антибиотиков антрациклинового ряда,
ограничивается высокой токсичностью.
На кафедре "Химия и
химические технологии" Севастопольского государственного
университета в
лаборатории
биоорганической, биофизической и медицинской химии
получены фармацевтические композиции доксорубицина с
природными сапонинами с целью
поиска его новых транспортных форм и снижения
токсического действия. Результаты исследования
опубликованы в Химико-фармацевтическом журнале (Pharmaceutical
Chemistry Journal).
Кроме того, было
изучено прямое цитотоксическое действие главных
сапонинов плюща и солодки на рост опухолевых клеток.
В
настоящее время в лаборатории разработаны новые
комплексы противоопухолевых фармацевтических субстанций
и проводятся их биологические испытания на ряде
клеточных линий.
Л.А. Яковишин
|
|


|
24.01.2022 г.
Сегодня в СевГУ нелетная погода.


|
|

 |
22.01.2022 г.
отмечается Всемирный день
попкорна. Когда появился попкорн (воздушная
кукуруза) точно не известно, но 22 января 1630 г. индейцы
подарили его европейским колонистам. Поэтому днем рождения
попкорна стали считать именно этот день.

Попкорна ведро и можно в кино!
Для
попкорна подходит не любая кукуруза, а только
лопающаяся (взрывная) кукуруза Zea mays var. everta. У ее зёрен практически весь эндосперм
стекловидный. Эндосперм – это ткань с питательными
веществами для развития зародыша.
В основном это крахмал.
Стекловидный эндосперм отличается высокой прочностью.
Мучнистый эндосперм, имеющий рыхлую консистенцию, у зерна
такой кукурузы отсутствует или
наблюдается в небольшом количестве только около зародыша.
Стекловидный эндосперм содержит больше белка.


При нагревании кукурузного зерна
содержащаяся в нем вода переходит в пар. Водяной пар
сдерживает оболочка зерна. Она толстая и прочная. Но в
определенный момент оболочка уже не выдерживает давление
пара. Она лопается, и вырывающийся водяной пар выворачивает
наружу эндосперм зерна в виде светлой рыхлой массы большого
объема. Объем этой массы превышает объем зерна в несколько
десятков раз! Так получается попкорн.

В разрезе
виден вспученный парами воды эндосперм кукурузного зерна
В зернах
кукурузы, а значит и в попкорне, содержится много полезных
веществ. Он богат крахмалом, в нем есть белок, клетчатка и
ряд витаминов.
Для
придания определенного вкуса в попкорн добавляют сахар, соль,
а также различные ароматизаторы.
Добавка сахара и жиров повышают калорийность попкорна. Для
придания привлекательно внешнего вида попкорн иногда
подкрашивают пищевыми красителями.
Л.А. Яковишин
|


|
21.12.2021 г. Перед предстоящими
новогодними праздниками в
Севастополе выпал долгожданный снег
- атмосферные осадки в виде небольших кристалликов льда.
Немного снежной науки. Вода, кристаллизуясь на частицах пыли,
которые присутствуют в воздухе, образует шестиугольные
структуры. Первоначальный кристалл имеет форму правильной
шестиугольной призмы. От нее растут уже новые кристаллики. Так
появляются всем знакомые снежинки.


|
|

 |
08-12 ноября
2021 г. в Уральском федеральном
университете
имени первого Президента России Б.Н. Ельцина
(г. Екатеринбург) и
в
Пермском государственном национальном исследовательском
университете (г. Пермь) состоялась
V
Международная
конференция
«Современные синтетические методологии для
создания лекарственных
препаратов и функциональных материалов» (MOSM
2021).

Преподаватели
кафедры
«Химия и химические технологии»
Севастопольского государственного
университета
(профессор Яковишин Л.А.,
доцент Ткаченко Э.В.)
и магистры
кафедры «Физика»
Ратников В. и Бажан П. представили на конференции
результаты изучения нового молекулярного комплекса тритерпенового
гликозида глицирама с рутином, а также композиционных материалов на
основе хитозана.

Рутин
|
|

 |
05.07.2021
г.
У кого-то уже начались летние каникулы, а в
лаборатории
биоорганической, биофизической и медицинской химии
кафедры "Химия и химические технологии" СевГУ
кипит работа. Здесь студенты
магистерской программы "Биофизика" 2 года обучения
Ратников Владимир и Бажан Полина
проходят практику, в ходе которой они изучают процессы
комплексообразования биологически активных молекул на
современном оборудовании - спектрофотометре и ИК-Фурье-спектрометре.

|

 |
24.06.2021
г.
в СевГУ на кафедре "Физика" состоялась защита выпускных
квалификационных работ у студентов направления подготовки "Физика" (профиль Биохимическая физика).
Поздравляем с успешной защитой Бабенко Алину. Дипломную
работу она выполнила в лаборатории
биоорганической, биофизической и медицинской химии
кафедры "Химия и химические технологии" (научный руководитель проф.
Яковишин Л.А.).


|

 |
09.06.2021 г.
Количество просмотров СевХимПортала составило
1 800
000.

|

 |
30
мая - День химика!
С
праздником!!!

|

 |
15 мая
2021 г. состоялся
Третий
Всероссийский химический диктант
по теме "Химия для настоящего и будущего".
Подобные
диктанты организуются с целью популяризации химии. В
этом году диктант включал 25 вопросов. На его
очное
или онлайн
написание отводилось 45 минут.
В Севастополе химдиктант проводился на
базе ГБОУ СОШ
№61
имени Героя
Советского Союза А.И. Маринеско
(куратор
Курковская
И.В.)
при поддержке
ГБОУ
ПО
"Институт развития образования"
(методист
Зубенко В.А.).
Его писали 88 человек, среди которых были не только школьники и студенты, но и взрослые участники,
интересующиеся химической наукой. Половину и более заданий правильно
выполнили 56 человек (64 %). Верные ответы на 20 и более вопросов
дали 5 человек (6 %).

Студенты
групп Ф/б-19
и
НЭ/б-19

Студенты
группы Ф/б-19
Активными участниками
диктанта были студенты Севастопольского государственного
университета. Свои знания проверили студенты групп
ПГС/б-20,
Ф/б-19, ВВ/б-20 и НЭ/б-19.

Студенты
группы
ПГС/б-20
Как
и два года назад, самым юным участником диктанта стал
Безусов Сергей.
Он учится во втором классе
СОШ №22.
На диктант юный химик пришел вместе с мамой, выпускницей
Севастопольского государственного университета,
которая выполняла дипломные работы бакалавра и магистра в
лаборатории
биоорганической, биофизической и медицинской химии.
Сейчас Юлия Безусова является методистом
Политехнического института СевГУ. Ее увлеченность химией
передалась и сыну. На диктанте Сергей
продемонстрировал свои успехи в изучении основ химии и получил очень
хороший результат. Молодец! Хочется пожелать юному химику дальнейших
успехов в учебе!

Сюжет о проведении
химического диктанта в
Севастополе можно посмотреть в программе
"Севинформбюро" на телеканале
НТС.
|
|

 |
25.04.2021 г.
Международный день ДНК
(дезоксирибонуклеиновой кислоты). В этот день в 1953
г. в журнале Nature (Т. 271, №
4256) были опубликованы статьи
Дж. Уотсона
и Ф. Крика, М. Уилкинса,
А. Стокса и
Х.
Уилсона, а также Р.
Франклин и Р. Гослинга,
посвященные
молекулярной структуре нуклеиновых кислот. В статье "Molecular
structure of nucleic acids: A structure for deoxyribose nucleic acid"
Дж. Уотсон и
Ф. Крик описали двойную спираль ДНК.
Поэтому 25 апреля стали
отмечать день ДНК. В 1962 г.
Дж. Уотсон,
Ф. Крик и М. Уилкинс
получили
Нобелевскую премию по физиологии и медицине за изучение строения и
свойств нуклеиновых кислот.
|

Буквой
«В» в цепочке ДНК условно
обозначено азотистое основание. В состав ДНК
входит дезоксирибоза, а РНК - рибоза. |
Нуклеиновые кислоты
– это биополимеры, осуществляющие хранение и передачу
генетической информации в живой клетке, мономерами которых
являются структурные единицы, состоящие из азотистого
гетероциклического основания пиримидинового или пуринового
типа, остатков рибозы или дезоксирибозы и фосфорной кислоты.

Модель
фрагмента структуры ДНК, подаренная профессору А.Н.
Веселкову лауреатом Нобелевской премии профессором М.
Уилкинсом
(фото 2005 г.). |
Основы для изучения ДНК в
Севастополе были заложены профессором
А.Н.
Веселковым, который
возглавлял кафедру физики СевНТУ
с 1991 по 2004 г.
Сейчас в Севастопольском
государственном университете продолжаются исследования в
области нуклеиновых кислот и их компонентов. На кафедре "Физика"
создана научная школа
по молекулярной биофизике.
На кафедре "Химия и
химические технологии" СевГУ в
лаборатории
биоорганической, биофизической и медицинской химии
получены молекулярные комплексы сапонинов с азотистыми основаниями
нуклеиновых кислот и рассматривается влияние сапонинов на состояние
хроматина.
Л.А. Яковишин
|

 |
22.03.2021 г.
Всемирный день воды или
Всемирный день водных ресурсов.
По решению Генеральной Ассамблеи ООН он начал отмечаться с 1993 г.
для привлечения внимания населения к проблемам снабжения пресной
водой, а также сохранения и рационального использования водных
ресурсов.

Какая самая распространенная жидкость на нашей
планете? Конечно, это вода. Ее химическая формула Н2О
известна почти всем. Однако не все знают, что вода иначе называется
оксидом водорода. Народная мудрость гласит, что «без воды – и ни
туды, и ни сюды». С этим нельзя не согласиться. Вода действительно
играет очень важную роль в нашей жизни. Она является участником
многих важных химических процессов, протекающих в организмах
человека, животных и растений. Она формирует климат на Земле. Она
так необходима в быту и промышленности. Запасы пресной воды невелики
– только около 2,5 %. Поэтому пресная вода нуждается в охране и
рациональном использовании.

В среднем животные и растения содержат более 50
% воды, а в некоторых представителях ее содержание близко и к 100 %.
Это, например, всем известные огурцы и арбузы. В организме человека
воды примерно 65 %, причем ее содержание зависит от возраста: чем
старше человек, тем меньше воды содержит его организм. У
новорожденных детей ее содержание доходит до 75 %, а у взрослых,
наоборот, воды меньше – до 60 %. Живые организмы очень чувствительны
к потере воды. Потеря организмом человека до 10 % воды вызывает
резкое ухудшение самочувствия (повышается температура, появляется
усталость и слабость), а потеря более 10 % воды приводит к смерти.

Водопад Козырек (окрестности
села Передовое Балаклавского района Севастополя)
Для доказательства наличия воды в организме
человека достаточно провести простой опыт. Возьмите стекло или
металлическую пластинку и выдохните на нее. Наблюдается конденсация
паров воды.
Л.А. Яковишин
|

 |
8 марта
2021
г. отмечает юбилей
кандидат химических наук, доцент кафедры «Химия
и химические технологии» Севастопольского
государственного университета Корж Елена
Николаевна.

Елена Николаевна
родилась 8 марта 1946 г. в г. Ереване.
В 1952 г. переехала в Севастополь, где окончила школу № 3. В 1964 г.
поступила в Севастопольский приборостроительный институт на
специальность «Физико-химические исследования металлургических
процессов (защита от коррозии)» и в 1969 г. окончила
его с отличием.
Трудовая
деятельность Елены Николаевны началась в 1969 г. в Черноморском
филиале НИИ технологии судостроения. В Севастопольском
приборостроительном институте она стала работать с 1972 г. и прошла
путь от стажера-исследователя до доцента.
В 1978 г. поступила в аспирантуру
Ленинградского политехнического института. В 1982 г. успешно
защитила диссертацию в Ленинградском технологическом институте на
соискание ученой степени кандидата химических наук по специальности
«Физическая химия». Научным руководителем работы был
известный электрохимик доктор химических наук, профессор А.М.
Сухотин. В 1994 г. получила звание доцента.

Елена Николаевна
является автором трех изобретений,
исполнителем грантов РФФИ и внутреннего гранта СевГУ. Награждена
нагрудным знаком «Изобретатель СССР». Имеет более 150
публикаций, среди которых монография на английском языке.
Областью ее научных интересов является физическая и
биоорганическая химия, а также методика преподавания химии в высшей
школе. Ее научные разработки внедрены
на производстве.
Кроме научной
деятельности, Елена Николаевна ведет активную воспитательную и
учебно-методическую работу. Она автор нескольких учебных
пособий. Ее пособие «Физическая химия» имеет гриф МОН.
В университете ее неоднократно отмечали
лучшим куратором. Много времени Елена Николаевна уделяла работе со
школьниками города, являясь тренером сборной команды учащихся
Севастополя на химических олимпиадах различного уровня, членом жюри
городской олимпиады по химии, а также научным руководителем
исследовательских работ. Она –
единственный представитель от Крыма в учебно-методическом совете
Федерального УМО по химии классических университетов России.
|
 |
Уважаемая Елена
Николаевна!
Коллектив кафедры
«Химия
и химические технологии» СевГУ
сердечно поздравляет Вас
с юбилеем.
Желаем Вам
крепкого здоровья, отличного настроения, неиссякаемого оптимизма,
счастья, успехов в научной
и методической деятельности!
|
|
|

 |
1 марта
начинается весна и отмечается
День кошек. Жизнь кота без химии не та!
И это действительно так, ведь кошки взаимодействуют с окружающим
миром с помощью смесей различных веществ
–
феромонов, которые
выделяют их железы. Для восприятия феромонов у них имеется
специальный орган, называемый вомероназальным органом (органом
Якобсона или вомером). Выделяя свои и анализируя феромоны собратьев, кошки
осуществляют химическую
коммуникацию.

Жизнь кота без химии не та!
Очень много феромоновых желез находится на
кошачьей мордочке.
Если кошка потерлась о вас мордочкой, то она
оставила там
свои химические метки. Различают пять лицевых феромонов кошек,
которые обозначают как F1-F5. В
основном они представляют собой смеси различных карбоновых кислот. Некоторые дополнительно
содержат триметиламин, 5-аминовалериановую кислоту и стероидное
соединение.

Лицевой
феромон
F2
Например, лицевой феромон
F2 (состоит из олеиновой,
пальмитиновой, пропионовой и пара-гидроксифенилуксусной
кислот) связан с половым поведением. Им самцы метят предметы во
время гона. А вот феромон F3 включает смесь одноосновных и двухосновных
карбоновых кислот: олеиновую, пальмитиновую, азелаиновую и
пимелиновую. Считают, что он успокаивает кошек.

Лицевой
феромон
F3

Облегчают жизнь коту феромоны на полу!
Успокаивает кошку феромон F3
немножко.
Но а
если скоро гон, то нужен новый феромон.
Получены синтетические аналоги
феромонов F3 и F4.
Их используют для коррекции поведения кошек.
Л.А.
Яковишин
|

 |
19.02.2021 г. В
Севастополе выпали кристаллы оксида водорода! Напомним, что
оксид водорода - это вода, а
снег - это атмосферные осадки в виде небольших кристаллов льда.

Учебный корпус
Севастопольского государственного университета
в балке Голландия

Черный дрозд ищет
ягоды плюща (территория СевГУ в балке Голландия)
|
|

 |
18 февраля
отмечается
День батарейки.
В 1799 г.
итальянский физик, химик и физиолог Аллесандро Вольта создал
химический источник электрической энергии. Устройство получило
название вольтового столба. Прибор состоял из медных и
цинковых дисков, между которыми находилось сукно, смоченное
раствором кислоты. Благодаря протеканию химической реакции в цепи
возникал электрический ток. Вольтов столб представляет собой
гальванический элемент и является прообразом современных батареек.
А. Вольта родился 18 февраля 1745 г., поэтому дату
его рождения стали считать Днем батарейки.
В 1802 г. русский физик Василий Владимирович
Петров собрал подобную батарею из 4200 цинковых и медных
дисков, разделенных картоном, пропитанным раствором хлорида аммония.
Его супербатарея получилась просто огромная. Суммарная длина ее четырех
столбов составила около 12 м, а по современным оценкам ЭДС она
давала до 1700 В! С помощью этой батареи В.В. Петров впервые получил
электрическую дугу.


Химические источники электричества можно легко
собрать из обыкновенных гвоздей, медной проволоки и фруктов или
овощей. Для батарейки подойдут яблоки, лимоны, картофель, репчатый
лук и т.п. Такая фруктовая или овощная батарейка будет давать
небольшое напряжение. Его можно измерить мультиметром. Но если
последовательно соединить несколько подобных батареек, то напряжение
будет больше и его станет достаточно для работы светодиодов,
калькуляторов, часов. Получены биобатарейки, способные питать даже
компьютеры.
Л.А.
Яковишин
|
|

 |
14.02.2021 г.
День влюбленных.
Любовь - всего лишь химия. Согласно психохимической гипотезе
Майкла Либовица из Колумбийского университета (Liebowitz
M.R.(1983) The
Chemistry of Love), при переживании чувства любви в мозге человека
синтезируется вещество 2-фенилэтиламин (РЕА).

2-Фенилэтиламин
2-Фенилэтиламин -
это нейромедиатор, который получается при
ферментативном декарбоксилировании протеиногенной аминокислоты
L-фенилаланина (Phe).
Установлено, что у недавно
влюбленных мужчин и женщин уровень гормона кортизола
повышается, что подтверждает их стрессовое состояние (Marazziti
D., Canale D. Hormonal changes when falling in love. Psychoneuroendocrinology (2004) Vol. 29, P. 931–936).
Спустя 12-24 месяца данное гормональное изменение уже не
наблюдается.

Кортизол
|
|

 |
08.02.2021 г.
День российской науки. Поздравляем научных
работников и преподавателей с
праздником! Желаем новых научных открытий и разработок!

2021
год в Российской Федерации объявлен Годом науки
и технологий

Праздник приурочен к дате
основания Российской академии наук. Она была учреждена Указом Сената
по повелению Петра I
8 февраля (28 января по старому стилю) 1724 г.
|
|

 |
30 января 2021 г. -
день Деда Мороза и Снегурочки.
Праздники продолжаются!

|
|

 |
17 и 18 декабря 2020 года
на химическом факультете МГУ им. М.В. Ломоносова (г. Москва) в
режиме видеоконференции состоялся пленум ФУМО по химии,
посвященный памяти академика В.В. Лунина. На пленуме было
зарегистрировано более 60 представителей из 44 регионов Российской
Федерации. В работе пленума от Севастополя и Крыма принимала участие
к.х.н., доцент кафедры «Химия и химические технологии»
Севастопольского государственного университета Е.Н. Корж как
постоянный член Учебно-методического совета ФУМО университетов
России по химии.

С приветственным словом выступил
председатель ФУМО, член-корреспондент РАН, д.х.н., профессор, декан
химического факультета МГУ С.Н. Калмыков. Заседание пленума
открыла зам. председателя ФУМО, д.х.н., профессор МГУ И.А.Успенская. С докладом
«Новые принципы формирования
контрольных цифр приема на 2021-22 учебный год» выступила зам.
декана механико-математического факультета МГУ В.Б.Беднова.
С целью обсуждения проблем и
перспектив развития электронного обучения с использованием
дистанционных образовательных технологий был организован круглый
стол «Опыт дистанционного обучения химиков: проблемы, решения,
перспективы». Заседание круглого стола было открыто к.х.н.,
доцентом, зам. заведующего по учебным вопросам кафедры
неорганической химии МГУ Е.В. Карповой, которая представила
доклад «Опыт дистанционного обучения студентов 1-го курса
химического факультета МГУ». В выступлении были отмечены
особенности организации учебного процесса на основе дистанционных
технологий, его плюсы и минусы, обозначена необходимость
разрабатывать новые технологии и методические подходы для
дистанционного обучения, которое должно стать дополнением к очному
высшему образованию.
По теме круглого стола был
заслушан доклад к.х.н., с.н.с., зам. декана по дополнительному
образованию химического факультета МГУ В.В. Миняйлова «Информационно-коммуникационные технологии в учебном процессе на
химических кафедрах». При изучении проблем дистанционного
обучения с 2004 г. и результатов анализа трудностей со слов
студентов всех курсов обучения, восприятий преподавателями
интенсивности учебного процесса в дистанционном формате В.В.
Миняйлов приходит к выводу, подтверждающему слова Франциско
Велозо, декана Бизнес-школы Имперского колледжа (Лондон):
«…чтобы перейти в цифровую среду нужно огромное количество ресурсов,
времени, знаний и приверженности». В докладе «Дистанционный
формат обучения: опыт, текущие задачи» д.х.н., зав. кафедрой
неорганической химии Ивановского государственного
химико-технологического университета А.С. Вашурин рассмотрел
влияние дистанционного образования на успеваемость студентов 1-3
курсов направления «Химия» и выделил основные проблемы
дистанционного формата обучения.
С большим вниманием был заслушан
доклад зам. председателя ФУМО, д.х.н., профессора МГУ И.А.
Успенской «Общее состояние дел: тенденции и проблемы», в
котором рассматривались современные тенденции развития образования –
формирование нового перечня специальностей и направлений подготовки
высшего образования, номенклатура научных специальностей и
особенности подготовки специалистов.
На пленуме были заслушаны и
другие доклады. Обсуждение всех материалов работы
пленума носило дискуссионный характер.
Е.Н. Корж
|
|

 |
15 декабря
2020 г.
отмечается Международный день
чая.
В Россию чай попал в
XVII
веке. В 1638 г. 4 пуда чая привезли царю Михаилу Федоровичу в
подарок от Алтан-хана из Монголии. Первой родиной чая на Руси можно
считать Крым. Именно там он был впервые высажен еще в 1814 г.
Произошло это в Никитском ботаническом саду. Однако крымский климат
и почва не подошли для чайных кустов, и промышленное разведение чая
было начато на Кавказе. Как и кофе, чай первоначально использовали в
качестве лечебного средства.

Тонизирующие
свойства чая и кофе связаны с наличием в листьях чая и зернах кофе
особых природных веществ – алкалоидов, среди которых главным
является кофеин (1,3,7-триметилксантин). Он также содержится
в орехах кола, какао-бобах, семенах гуараны и стеркулии и листьях
падуба парагвайского, из которого готовят напиток мате. Содержание
кофеина в чае может достигать 5
%, а в семенах гуараны – более 6 %.
Кофеин возгоняется при
температуре 180°С. При этом образуются
красивые игольчатые кристаллы.
Л.А.
Яковишин
Мир кристаллов дома и в школе.
Занимательные эксперименты.
– Севастополь:
Рибэст, 2013.
|
|

 |
30
ноября
2020 г.
отмечается Всемирный день домашних
животных.

Достижения современной химии
активно внедряются в ветеринарию и позволяют значительно улучшить
качество жизни животных. Это и новые эффективные лекарственные
препараты и биологически активные комплексы, средства по уходу за
животными, пищевые добавки, материалы для игрушек и амуниции.

К сожалению,
домашние
животные, как и люди, подвержены различным заболеваниям. В последнее время в
разных регионах России наблюдается значительный рост клещевых
инфекций у собак. Среди трансмиссивных клещевых болезней особое
место занимает эрлихиоз. Возбудителями эрлихиоза являются
внутриклеточные паразиты рода Ehrlichia.
Ehrlichia muris и
Ehrlichia canis
поражают моноциты и вызывают моноцитарный эрлихиоз собак.
Эрлихиозом наиболее часто и тяжело болеют немецкие овчарки.
Ветеринарная клиника «БИОН»
(ветеринарный
врач
Адрузов И.В.)
и кафедра «Химия и химические технологии»
Севастопольского государственного
университета
(профессор Яковишин Л.А.) провели совместное исследование
физиологических и биохимических
особенностей организма собаки при наличии у нее эрлихиоза.
Проанализированы результаты клинического и биохимического анализов
ее крови. Проведено сравнение полученных данных с
ранее известными. Показана
эффективность комплексной терапии при эрлихиозе.
|

 |
18-21
ноября
2020 г.
в Уральском федеральном
университете
имени первого Президента России Б.Н. Ельцина
(г. Екатеринбург) при
поддержке Российского фонда фундаментальных исследований прошла
Международная
конференция
«Актуальные
вопросы органической химии и биотехнологии».
Кафедра
«Химия и химические технологии»
Севастопольского государственного
университета
(профессор Яковишин Л.А. и доцент Корж Е.Н.) представила на этой
конференции доклады, посвященные исследованию
комплексов тритерпеновых сапонинов с аминокислотами и кверцетином.

|
|

 |
16-20
ноября
2020
г.
в Уральском федеральном
университете
имени первого Президента России Б.Н. Ельцина
(г. Екатеринбург) на
базе Инновационного центра химико-фармацевтических технологий
состоялась
IV
Международная
конференция
«Современные синтетические методологии для
создания лекарственных
препаратов и функциональных материалов» (MOSM
2020).
Преподаватели
кафедры
«Химия и химические технологии»
Севастопольского государственного
университета
(профессор Яковишин Л.А. и доцент Корж Е.Н.) представили на конференции
результаты изучения межмолекулярного взаимодействия
тритерпеновых гликозидов с холестерином в различных средах. Работа
была выполнена в рамках научно-исследовательского проекта СевГУ.
 |

 |
09.10.2020
г. Всемирный
день яйца. Праздник отмечается во вторую пятницу
октября по решению Международной яичной комиссии.
Яйца являются очень важным
продуктом питания. Они содержат белки, жиры, витамины и
другие вещества. В яйцах найдено более 35 химических элементов.
Окраска яичного желтка
обусловлена каротиноидами. В основном на цвет желтка
влияют ксантофиллы. Среди них преобладают зеаксантин
и лютеин. В меньшем количестве содержится ксантофилл криптоксантин, а также
бета-каротин. Белок яйца имеет
зеленоватый оттенок из-за растворенного в нем витамина В2
(рибофлавина).

|
|

 |
10.09-13.09.2020
г. в Краснодаре состоялась
XVII Международная конференция
"Спектроскопия
координационных соединений".
Организаторами конференции выступили
Институт
общей и неорганической химии им. Н.С. Курнакова РАН и Кубанский
государственный университет. Кафедра "Химия и
химические технологии" СевГУ (проф. Яковишин Л.А.,
доц. Корж Е.Н.) представила на конференции доклад "Супрамолекулярный
комплекс глицирама с холестерином".
 |

 |
07.09.2020
г. Международный день чистого
воздуха для голубого неба. Дата установлена
резолюцией ООН для привлечения внимания общества к проблеме
загрязнения воздуха.
Напомним, что воздух
представляет собой смесь 78 %
азота N2
(по объему), 21
% кислорода О2
и 1 % прочих веществ (аргона Ar
(0,9 %) и других инертных газов, углекислого газа СО2,
водорода Н2, метана СН4 и др.). Молярная масса воздуха в
среднем составляет 29 г/моль.

|
|


|
29 июля
2020 г. памятнику
затопленным кораблям исполнилось 115 лет. Он
является самым известным памятником Севастополя и его главным
символом.
Памятник представляет собой
искусственную гранитную скалу, на которой на восьмигранном
пьедестале установлена
семиметровая диоритовая колонна с коринфской капителью. На
бронзовой капители находится двуглавый бронзовый орел, держащий
венок в клювах (одна половина из лавровых листьев, а другая - из
дубовых). Орел увенчан императорской короной, на его груди
находится щит с изображением Георгия Победоносца. К венку на
цепи прикреплен якорь. Авторами памятника являются скульптор А. Адамсон, архитектор
В.Фельдман и инженер О. Энберг.
Таким образом, памятник
выполнен из бронзы (база колонны, капитель, скульптура орла,
барельеф с изображением затопления кораблей на восьмигранном
пьедестале), диорита (колонна) и гранита (скала, таблички по
бокам с надписями "1854" и "1855"). Со
стороны моря раньше располагалась еще бронзовая мачта, но она
была утрачена.
|
Немного химии.
Диорит -
магматическая горная порода, состоящая в основном из плагиоклаза
и роговой обманки, являющихся алюмосиликатами. Состав диорита:
SiO2, Al2O3,
Fe2O3, FeO, MgO, CaO, Na2O, K2O,
TiO2, MnO, P2O5 и H2O.
Гранит - кислая
магматическая горная порода, состоящая в основном из кварца (SiO2)
и полевого шпата (алюмосиликаты). Как и диорит, гранит имеет
состав: SiO2, Al2O3, Fe2O3,
FeO, MgO, CaO, Na2O, K2O, TiO2,
MnO, P2O5 и H2O.
В отличие от диорита, гранит содержит много кварца.
Бронза - это медный сплав с
оловом или другими металлами (Al, Be, Pb
и др.). Под воздействием атмосферного кислорода и углекислого
газа, а также паров воды, медь и медные сплавы со временем
приобретают характерный зеленоватый или голубой оттенок. Это
образуется патина, представляющая собой основные карбонаты меди
(II): |

 |
2Cu + CO2 + O2
+ H2O = Cu2(OH)2CO3
6Cu + 4CO2 + 3O2
+ 2H2O = 2Cu3(OH)2(CO3)2.

Патина на бронзовом
барельефе Памятника затопленным кораблям
|
|

 |
17-18.06.2020
г.
в СевГУ на кафедре "Физика" состоялась защита выпускных
квалификационных работ у студентов направления подготовки "Физика" (профиль Биохимическая физика).
Поздравляем с успешной защитой специализантов лаборатории
биоорганической, биофизической и медицинской химии Бажан П. и Ратникова В.
(научный руководитель проф.
Яковишин Л.А.).

|
|

 |
|
31
мая - День химика!
С
праздником!!!
"Химия
– это область чудес, в ней скрыто счастье человечества,
величайшие завоевания разума будут сделаны именно в этой
области"
(М. Горький)
|
 |
|
|


|
21-22.05.2020 г.
В
Обнинском институте атомной энергетики (ИАТЭ НИЯУ МИФИ)
состоялась
III Международная
научная конференция «Техногенные системы и экологический риск»
(г. Обнинск,
Россия).
Кафедра «Химия и
химические технологии»
Севастопольского государственного университета приняла участие в
работе этой конференции в секциях
«Экологическая
и фармацевтическая химия»
и
«Техногенный
и экологический риски. Радиационная безопасность».

ИАТЭ
НИЯУ МИФИ
|
|

 |
14.05.2020 г.
"День рождения" вазелина.
В этот день в 1878 г.
английским химиком
Робертом
Августом Чезбро (1837-1933),
эмигрировавший в США, была
запатентована торговая марка "Vaseline".
Поэтому 14 мая считают "днем рождения" вазелина.
Однако слово
"вазелин" ("vaseline") было раньше упомянуто
в его американском патенте №127568 (U.S. Patent 127,568) "Improvement
in products from petroleum" от 4 июня 1872 г. Так
Р. Черзбро
назвал изобретенный им ранее в 1859 г. продукт переработки нефти,
который сначала назывался "нефтяным желе" ("petroleum
jelly"), но такое
название не принесло ему коммерческого успеха.
Слово "вазелин" происходит от немецкого "wasser"
- вода и греческого "elaion"
- оливковое масло.
Поэтому датой
появления вазелина можно считать и 4 июня.

Вазелин представляет
собой полупрозрачную бесцветную или светло-желтую мазеобразную
массу, состоящую из очищенной смеси высших углеводородов -
твердых парафинов (преимущественно нормальных алканов С18-С35)
и жидкого минерального масла (в основном алкилциклоалканов (алкилнафтенов)
и алкиларенов). Не имеет вкуса и запаха. Не растворяется в воде.


|
 |
Вазелин является
самостоятельным лекарственным средством, обладающим
дерматопротекторным и смягчающим кожу действием. Ускоряет заживление
ран. Кроме того, он - классическая основа различных лекарственных
(например, салициловой, борной, цинковой и эритромициновой) и косметических мазей. Вазелин
используют в ветеринарии. |
Он также применяется для защиты металлов от коррозии, как смазка, для пропитки
бумаги и тканей. Входит в состав скульптурного пластилина.
Пищевая добавка Е905b
- это вазелин.
Относится к глазирующим агентам. Сейчас в
России она не
используется.
|
|

 |
17.04.2020 г.
Кафедра «Химия и химические технологии»
Севастопольского государственного университета
поздравляет с юбилеем
заведующего учебной лабораторией «Химия»
Ковальчука С.А.
|
 |
Уважаемый
Станислав
Александрович!
Искренне желаем Вам
крепкого
здоровья, счастья, прекрасного настроения и
процветания!
Пусть воплотятся все Ваши мечты!
|
|
|

 |
08.02.2020 г.
День российской науки. Поздравляем коллег с
профессиональным праздником! Желаем новых научных открытий!

Праздник приурочен к дате
основания Российской академии наук. Она была учреждена Указом Сената
по повелению Петра I
8 февраля (28 января по старому стилю) 1724 г.

|
 |
В
Севастопольском государственном университете работают 1
доктор и 5 кандидатов химических наук. |
|
|


|
24.01.2020 г.
–
Международный день
мороженого эскимо.
Эскимо – глазированное мороженое на палочке. Слово происходит от
англ. eskimo pie – «эскимосский пирог». 24.01.1921 г. в США
Крису Нельсону был выдан патент
на эскимо. Традиционное эскимосское мороженое
(акутак) делают на основе жира с добавлением ягод, трав,
корней, мяса, рыбы и сахара.
Немного «эскимосской
химии». Сейчас в состав эскимо входят сливки, молоко, сахар,
эмульгаторы (моно- и диглицериды жирных кислот Е471), стабилизаторы
(камедь рожкового дерева, гуаровая камедь, каррагинан и др.),
ванилин и др. компоненты. Шоколадная глазурь изготавливается из
сахара, какао тертого, какао масла, молочного жира, эмульгаторов
(соевый лецитин, полиглицерилполирицинолеаты Е476) и др.
компонентов.
 |

 |
17.01.2020 г.
обновлен раздел "Спецюмор"
на СевХимПортале.
Вот один из последних ответов студентов на экзамене по химии
в СевГУ: "Мельдоний - это
элемент, названный в честь Д.И. Менделеева".
Напомним, что в честь великого русского химика
Д.И. Менделеева назван элемент менделевий
(Md), имеющий в периодической
системе порядковый номер 101, а мельдоний - это органическое
вещество, улучшающее метаболизм. Его назначают в качестве
лекарственного средства при инфаркте, инсульте, сердечной
недостаточности, алкогольной абстиненции и физическом
перенапряжении.


|
|

 |
28.12.2019 г.
количество посетителей
СевХимПортала составило 1700000.

|
|

 |
С 27 по 30 ноября 2019 г. в
Москве на химическом факультете Московского государственного
университета им. М.В. Ломоносова состоялся очередной
пленум Федерального учебно-методического
объединения по химии Российской Федерации. В работе
пленума от Севастопольского государственного университета
приняла участие к.х.н., доцент кафедры «Химия и химические
технологии», член ФУМО по химии Е.Н. Корж. На пленуме
присутствовали представители более 50 классических университетов
Российской Федерации.

Участников пленума поприветствовали проректор
МГУ – начальник Управления учебно-методической деятельности и
дополнительного образования К.В. Миньяр-Белоручев и Президент
химического факультета МГУ им. М.В. Ломоносова, академик РАН В.В.
Лунин.
На заседаниях пленума были заслушаны доклады:
Е.А. Шкабура − начальника отдела стратегического развития
высшего образования Департамента государственной политики в сфере
высшего образования Министерства науки и высшего образования РФ; А.М. Чередника − исполнительного директора Фонда Андрея
Мельниченко.
Большой интерес вызвали выступления: зам.
председателя ФУМО «Химия», д.х.н., профессора МГУ им. М.В.
Ломоносова И.А. Успенской о проблемах разработки ОПОП в
соответствии с требованиями ФГОС3++, по вопросам универсальных,
общепрофессиональных и профессиональных компетенций и индикаторах их
достижения; доклад А.Г. Худошина «Relaxys как инструмент для
повышения качества образования и конкурентоспособности выпускников»;
выступление Р. Гагкуева, главного редактора концерна «Российский
учебник» и др.
В дискуссиях по проблемным вопросам российского
образования приняли активное участие представители вузов России.
Затем участники пленума были приглашены на
торжественную церемонию, посвященную закрытию Международного года
Периодической таблицы химических элементов в России и 90-летнему
юбилею химического факультета МГУ им. М.В. Ломоносова, в которой
приняли участие представители правительства РФ, руководства РАН и
крупных химических компаний.
Е.Н. Корж |
|

 |
13-16
ноября
2019 г.
в Уральском федеральном
университете
им. первого Президента России Б.Н. Ельцина
(г. Екатеринбург) на
площадке Инновационного центра химико-фармацевтических технологий
проходила
III
Международная
конференция
«Современные синтетические методологии для создания лекарственных
препаратов и функциональных материалов» (MOSM 2019).
Преподаватели
кафедры
«Химия и химические технологии»
Севастопольского государственного
университета
(профессор Яковишин Л.А. и доцент Корж Е.Н.) представили на этой
конференции доклады
«Molecular
complex of salicylic acid with
glycyram»
и
«Molecular
complex of quercetin with
hederasaponin C».

|
|

 |
16-19
октября
2019 г.
в Шанхае (Китай) состоялся
XIII
Международный симпозиум по химии природных соединений
(XIII
International Symposium on the Chemistry of Natural Compounds).
Организаторами симпозиума выступили
Центральноазиатский центр исследования и разработки лекарственных
средств Академии наук Китая, Институт химии растительных веществ
Академии наук Республики Узбекистан и Университет Анадолу (Турция).

XIII International Symposium on the Chemistry of Natural
Compounds
第十三届天然化合物化学国际研讨会

Преподаватели кафедры
"Химия и химические технологии" СевГУ
(профессор Яковишин Л.А., доцент Корж Е.Н.)
представили на симпозиуме доклад "New
molecular complexes of quercetin
with ivy triterpene saponins".
Соавторами доклада были студенты 4 курса Ратников В. и Бажан П., выполняющие дипломные работы в лаборатории
биоорганической, биофизической и медицинской химии СевГУ.
|
|

 |
03.07.2019
г.
Студенты гр. Ф/б-31-о (профиль Биохимическая физика) проходят
практику в лабораториях биоорганической, биофизической и медицинской
химии и фармацевтической химии СевГУ. В ходе выполнения практики
студенты знакомятся с устройством и работой современного
ИК-Фурье-спектрометра, проводят хроматографический анализ
лекарственных препаратов.
 |
|

 |
|
26
мая - День химика!
С
праздником!!!
"Широко
простирает химия руки свои в дела
человеческие..."
(М.В.
Ломоносов) |
 |
|


|
18.05.2019
г.
В Севастополе в средней общеобразовательной школе № 61
имени Героя
Советского Союза А.И. Маринеско
состоялся
II
Всероссийский химический диктант.
Мероприятие организовано
Химическим
факультетом Московского
государственного университета имени М.В. Ломоносова,
корпорацией
"Российский
учебник" и Ассоциацией учителей и преподавателей
химии. Всем участникам были вручены Сертификаты.


Кафедру
"Химия" Севастопольского государственного университета на
мероприятии представляла инженер 2 категории Безусова Ю.И.
Самым юным участником диктанта стал Безусов Сергей. Юному
химику всего шесть лет, а он уже знает химические элементы,
формулы веществ, что такое "валентность" и легко собирает
шаростержневые модели различных молекул. Так держать! Пожелаем
Сергею дальнейших успехов в изучении замечательной науки - химии!
В фойе школы была
организована выставка рисунков "Химия глазами детей" и представлена
информация о 150-летии Периодической системы химических элементов
Д.И. Менделеева и 185-летии со дня его рождения.
|

 |
Кафедра «Химия» СевГУ поздравляет
зав. кафедрой Яковишина Л.А.
с присвоением ученой степени доктора химических наук по
специальности 14.04.02
–
фармацевтическая химия, фармакогнозия (приказ
Минобрнауки РФ № 169/нк от
06.03.2019).

Защита диссертации на тему: «Молекулярные
комплексы тритерпеновых гликозидов с биологически активными
веществами: получение, химико-фармацевтические свойства и
биологическая активность»
состоялась в диссертационном совете при ФГБОУ
ВО «Казанский национальный исследовательский
технологический университет» (г.
Казань).

|

 |
30.04.2019 г. Фасад главного учебного корпуса Севастопольского
государственного университета
на ул. Университетской, 33 обновился. На нем
появился логотип СевГУ:

В начале сентября 2017 г. в рамках
благоустройства территории СевГУ
кафедра «Химия»
(зав. кафедрой Яковишин Л.А.) предлагала
установку
на фасаде здания главного учебного корпуса крупной
подсвечивающейся вывески с
наименованием университета и его логотипом.

Предложение зав. кафедрой Яковишина
Л.А.
Вот так сейчас выглядит главный
корпус СевГУ:

|
|

 |
3–5
апреля
2019
г.
Кафедра
«Химия» СевГУ приняла участие в
ежегодной
научной конференции
Московского государственного университета имени М.В.
Ломоносова «Ломоносовские чтения» 2019
года, которая состоялась в
Филиале МГУ в городе Севастополе.
На конференции
были представлены следующие
доклады:
-
"СОВЕРШЕНСТВОВАНИЕ ПРОЦЕССА ОБУЧЕНИЯ ХИМИИ В ТЕХНИЧЕСКИХ ВУЗАХ"
(доц. Корж Е.Н.);
-
"РЕАЛИЗАЦИЯ КОНЦЕПЦИИ СОПРОВОЖДЕНИЯ ОДАРЕННЫХ ШКОЛЬНИКОВ В
СЕВАСТОПОЛЬСКОМ ГОСУДАРСТВЕННОМ УНИВЕРСИТЕТЕ" (ст. преподаватель
Ткаченко Э.В., доц. Толстенко Ю.В.);
-
"ОБУЧАЮЩИЙ ПРОЕКТ «ПОЛУЧЕНИЕ «ФАРАОНОВЫХ ЗМЕЙ» ИЗ ЛЕКАРСТВЕННЫХ
ПРЕПАРАТОВ" (зав. кафедрой Яковишин Л.А.).

|

 |
19–21 марта 2019 г.
Кафедра «Химия» СевГУ приняла участие в
Международной научно-практической конференции «Естественнонаучное
образование в современном мире», которая состоялась в Мурманском
арктическом государственном университете (г. Мурманск).

|
|

 |
19.02.2019 г.
На кафедре «Химия»
Севастопольского государственного университета состоялся I тур
студенческой олимпиады «Общая и неорганическая химия».

В олимпиаде приняли участие студенты 1–2 курсов
Политехнического
института, Института ядерной энергии и промышленности и
Института радиоэлектроники и информационной безопасности, а также
учащиеся школы
олимпийского интеллектуального резерва СевГУ.

Итоги олимпиады:
1 место: не
присуждалось.
2 место:
Крапивницкая О.Е. (Ф/б-21-о), Кузьменко М.Д. (ХТ/б-11-о),
Репинская В.С. (ХТ/б-21-о), Смирнов И.И. (ХТ/б-11-о),
Крыловецкий А.В. (ТП/б-21-о).
3 место:
Кошевая Д.О. (БС/б-21-о), Разина В.А. (ХТ/б-21-о),
Ажищева М.В. (Ф/б-11-о), Кухаренко А.А. (ТП/б-12-о).
Поздравляем победителей! |
|

 |
08.02.2019 г.
День российской науки. Поздравляем коллег с профессиональным
праздником! Желаем новых научных открытий и разработок!

Праздник приурочен к дате
основания Российской академии наук. Она была учреждена Указом Сената
по повелению Петра I
8 февраля (28 января по старому стилю) 1724 г.

|
|

 |
08.02.2019 г.
- 185 лет со дня рождения великого русского химика
Дмитрия Ивановича Менделеева.
Д.И. Менделеев (1834-1907) всем известен
как создатель Периодического закона и Периодической системы
химических элементов. Однако, он был не только великим
химиком, но еще и экономистом. Д.И. Менделеев
даже говорил: "Какой я химик, я -
политэконом..." Он
участвовал в разработке таможенного тарифа 1891 г. Им написан
«Толковый тариф, или
исследование о развитии промышленности России в связи с её общим
таможенным тарифом 1891 года».
Кроме того, Д.И. Менделеев внес важный
вклад в развитие кораблестроения в России. Он сотрудничал
с вице-адмиралом С.О. Макаровым и академиком А.Н. Крыловым.
Именно Д.И. Менделееву принадлежала идея постройки первого
российского опытового бассейна, который был открыт в 1894 г. в
Санкт-Петербурге в Новой Голландии. В начале
XX века Д.И. Менделеев разработал
проект арктического ледокола.
В 1865 г. Д.И. Менделеев
защитил докторскую диссертацию на тему "Рассуждение о
соединении спирта с водою", поэтому ему ошибочно приписывают
создание 40-градусной водки. Его диссертация действительно была
посвящена физико-химическим свойствам смесей этилового спирта и
воды, но раствор спирта с концентрацией 40 объемных процентов он
не исследовал.
Свою педагогическую
деятельность Д.И. Менделеев начал в Крыму. После окончания в
1855 г. Главного педагогического института в Санкт-Петербурге
его направили работать старшим учителем в симферопольскую
мужскую гимназию (ныне - симферопольская гимназия №1 имени И.В.
Курчатова).
В настоящее время в
Севастополе есть улица Менделеева. Находится она на Северной
стороне города в районе площади Захарова.
|

 |
2019 год объявлен ООН
Международным годом Периодической системы химических элементов Д.И.
Менделеева.

|
|
|
Городу-герою
Севастополю
242 года!
...Устроить
крепость большую Севастополь, где ныне Ахтияр, и где должны
быть адмиралтейство, верфь первого ранга кораблей, порт,
военное селение...
Указ
Екатерины II
10.02.1784 г.
|

1783-2025
 |
Город, достойный поклонения!
Датой
основания города Севастополя считается 3(14) июня 1783 г.
Тогда были заложены Фундаменты первых строений: пристани,
часовни Св. Николая Чудотворца, дома командующего эскадрой и
кузницы. |
|
|

«Докторская»
колбаса

Астаксантин: краситель
красного цвета и
суперантиоксидант
|